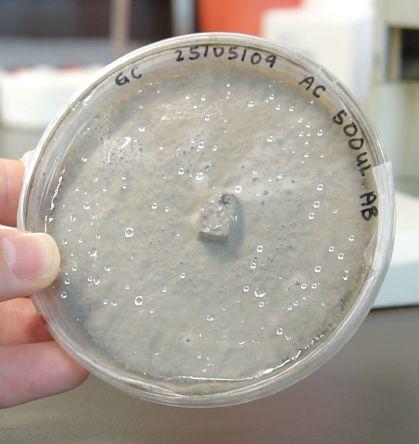

Research: Digging deep into take-all patch studies P14

Landscaping: Cleaning up after extreme weather P18
Buyers’ Guide: Our annual guide & directory P24
![]()
Research: Digging deep into take-all patch studies P14

Landscaping: Cleaning up after extreme weather P18
Buyers’ Guide: Our annual guide & directory P24
SUMMER TURF CARE
This pressure washer features an easy, convenient two-piece lance and gun assembly. The lance design is also extended for better accuracy in tall applications.

The Easy Start Pump System features a pressure relief valve, allowing users to start the unit without any back pressure from the pump. It enables quick, easy starting with no hard cord pulls.
This pressure washer includes stainless steel nozzles for use with high-pressure water and a brass nozzle for use with detergent. These premium nozzles are designed to resist corrosion and wear.
Both inlet (water coming into the pump) and outlet (water going from the pump to the gun) connections are easy to access for faster setup.
This pressure washer features a STIHL-engineered four-point vibration isolation system. This reduces pump vibration during use for increased unit longevity.

With the STIHL RB 400 gas high-pressure cleaner, you can thoroughly and conveniently clean surfaces and objects around the house and in the garden. Designed for domestic use, the cleaner features a powerful 4.8 kW (6.5 hp) gas engine that can generate a maximum working pressure of 185 bar.
The high-pressure cleaner can be started easily and effortlessly. The STIHL RB 400 takes in the right cleaning agent for your application from external containers. And when you need to take a break, the machine is also equipped with a convenient holder and parking position for the spray lance.
After use, you can store the high-pressure nozzles and the high-pressure hose on your RB 400 using the practical storage features. Thanks to the folding guide bar, the high-pressure cleaner is also easy to store and transport.
With a wide range of accessories, such as various nozzles and surface cleaners, you can even more effectively adapt the STIHL RB 400 to your specific cleaning task.
Without fuel.




By Mike Jiggens
This issue’s cover story profiles an assistant golf course superintendent from the Oakville Golf Club who volunteered his services at June’s U.S. Open Championship at the Oakmont Country Club in Pennsylvania.
Many superintendents and aspiring assistants are eager to volunteer their time at PGA Tour events – especially when they’re major championships – for several reasons. They get a close-up look at how the host superintendents at these venues respond to the stringent agronomic demands placed upon them by the Tour. They get to network with scores of their peers from throughout North America and overseas, sharing stories and ideas. They have the chance to enhance their people management skills, seeing first-hand how the host superintendent deals with such a large complement of professionals. And they add that all-important item to their resume – having worked a PGA Tour event.
In the case of Connor Brown, who is the subject of this issue’s cover story, his experience could go a long way in his climb up the ladder to one day becoming a full superintendent. He’s already got another Tour
event under his belt – the Waste Management Phoenix Open – and he’s hoping to complete the “grand slam” of major events, needing to volunteer at The Masters, the PGA Championship and the Open Championship.
Something Brown already has going for him is an actual work placement at Oakmont. It is where he did his university internship a year ago, giving him ample familiarity with the golf course prior to the U.S. Open.
He’s hoping to complete the ‘grand slam’ of major events
Volunteering at PGA Tour events or high-end amateur championships is only one avenue where assistants can bolster their professionalism. Another is the Green Start Academy which offers worldclass training to an elite group of assistant superintendents.
Sponsored by John Deere, Envu and Rain Bird, the program has empowered assistant superintendents for the past 20 years to unlock their potential and make huge strides in golf course management.
Assistant superintendents understand the value of their position and the important role they play in golf course

management. Most, however, wish to further their careers by becoming superintendents one day. They want to reach for the top yet realize they must first pay their dues as an assistant. Even if they move on from assistant at a high-end private club to the superintendent’s role at an average public course, it’s still a step forward.
It’s a key advancement in their professional development and denotes a commitment to assuming greater leadership and responsibility in several areas, including the management of the course’s playing surface, its grounds maintenance staff and budgets.
Once becoming a superintendent, the former assistant will have the chance to implement innovative practices, troubleshoot challenges that spring up and leave his stamp on the property.
The climb up the ladder strengthens an assistant’s communications and problem-solving skills and is a testament to his passion for the industry and his willingness to embrace what needs to be done for the betterment of the golf course.
Connor Brown has taken a big step forward in his journey to one day becoming a superintendent. His eagerness to volunteer at the U.S. Open and other events, not to mention his goal of completing the “grand slam” of major tournament volunteerism, speaks volumes of his dedication to his craft.
www.turfandrec.com
Reader Service
Print and digital subscription inquiries or changes, please contact Angelita Potal, Customer Service Tel: 416-510-5113 apotal@annexbusinessmedia.com
Mail: 111 Gordon Baker Rd., Suite 400 Toronto, ON M2H 3R1
Editor Mike Jiggens mjiggens@annexbusinessmedia.com
Advertising Manager Rebecca Lewis 519-400-0322 rlewis@annexbusinessmedia.com
Account Coordinator Emily Guimarães 416-510-5118 eguimaraes@annexbusinessmedia.com
Audience Development Manager Anita Madden 416-510-5183 amadden@annexbusinessmedia.com
Group Publisher Anne Beswick 416-410-5248 abeswick@annexbusinessmedia.com
CEO Scott Jamieson sjamieson@annexbusinessmedia.com
Printed in Canada ISSN 1186-0170
PUBLICATION MAIL AGREEMENT #40065710
SUBSCRIPTION RATES
Published 7 times a year – Jan/Feb, March, Apr/May, June/July, Aug/Sept, October, Nov/Dec Canada – 1 year $35.70 CDN; 2 year $45.90 CDN; 3 years $56.61 CDN (plus applicable taxes; single-copy$7.00 CDN USA – 1 year $48.96 CDN HST 86717 2652 RT0001
Occasionally, Turf and Recreation will mail information on behalf of industry related groups whose products and services we believe may be of interest to you. If you prefer not to receive this information, please contact our circulation department in any of the four ways listed above.
Annex Privacy Office privacy@annexbusinessmedia.com Tel: 800.668.2374
No part of the editorial content of this publication may be reprinted without the publisher’s written permission © 2025 Annex Business Media. All rights reserved. Opinions expressed in this magazine are not necessarily those of the editor or the publisher. No liability is assumed for errors or omissions.
All advertising is subject to the publisher’s approval. Such approval does not imply any endorsement of the products or services advertised. Publisher reserves the right to refuse advertising that does not meet the standards of the publication.




Experience thick, green grass with our low-odour mix of granulated compost and Selectus™ Rapid Fix - a premium ryegrass blend for rapid germination and resilience against heat, drought, disease, and insects.

With a balanced N-P-K ratio, calcium, and magnesium, Turf Pride provides slow-release nutrients for robust growth. It’s easy to apply with any spreader, enhancing soil health and moisture retention.
• Rapid Results: Fast-growing, top-rated turf seed!
• Stronger, healthier grass: Improves soil health and moisture retention.
• Resistant & resilient: Protects against weather, pests, and disease.
Make your lawn extraordinary with Turf Pride Seed and Feed!
• Easy application: Evenly apply with broadcast or drop spreaders. Call your Plant Products representative today! Everything you need to grow


Baseball games are often cancelled due to rain, but in Cambridge, Ont. they’re being called because of snapping turtles. A diamond at Riverside Park closed after it was learned a snapping turtle was using the skinned infield as its nesting grounds. City officials say the diamond would be closed for play for six to eight weeks.
In the meantime, the nesting area was cordoned off to protect the turtle’s eggs. Snapping turtles, which can live beyond 100 years, are considered at risk.
Invasive Japanese beetles have been discovered in the downtown core of Kamloops, B.C.
A major threat to turfgrass and hundreds of other plant species, the discovery has prompted the Canadian Food Inspection Agency to establish a containment zone around the core to prevent the pest’s spread.
Japanese beetles were discovered for the first time last year outside British Columbia’s Lower Mainland.
The grounds maintenance crew at the Alberni Golf Club in Port Alberni, B.C. walked off the job in July, striking against several sticking points unresolved between both parties.
A picket line was set up at the club early on a Monday morning. Grounds crew members had filed to join SEIU Local 2 last November and have attempted to reach an agreement with the club since then. A union official said such things as wages and benefits were among matters that led to the strike.
The 20th Green Start Academy, where aspiring assistant golf superintendents can develop the skills necessary to advance their careers, gets underway in December.
Sponsored by John Deere, Envu and Rain Bird, the program is entering its fifth year at the Pinehurst Resort in North Carolina. For two decades, the program has continued to enhance and sharpen the skills of assistant superintendents, equipping them with the essential knowledge and tools they need to excel. The program helps to empower assistants to unlock their potential and succeed in the world of golf course management.
“The success of Green Start Academy alumni continues to speak for itself, and we’re proud to carry on this tradition with a new class of assistant superintendents,” Kim Ehasz, global manager of market development and strategy at John Deere, said.

This year, the academy is set to bring together some of the finest assistant superintendents from throughout the United States and Canada, offering a unique education and networking experience. Participants will have the opportunity to immerse themselves in lectures and round-table discussions conducted by some of the golf industry’s most respected figures. The program is designed to provide the best environment for assistant superintendents to

impart essential knowledge and facilitate the sharing of industry best practices, with a clear focus on professional development. Green Start Academy equips each participant with the essential tools and insights to thrive in their respective careers.
“Envu is proud to support the Green Start Academy as it celebrates 20 years of advancing excellence in the golf course maintenance profession,” Mark Schneid, head of North America commercial operations at Envu, said.
The program offers a platform designed to guide participants toward both personal and professional growth and fosters meaningful connections to help strengthen bonds among industry leaders.
“This is one of my favourite weeks of the year,” Tony Whelan, national sales manager at Rain Bird, said. “Spending time with the mentors, our friends at John Deere and Envu at Pinehurst, the home of American golf. What could be better?”

The Andersons Genesis Rx® 5-7-5 is ideal for use during aerification to help your turf repair more quickly.
The difference after just 3 weeks is clear. Sand alone compared to sand with Genesis Rx 5-7-5 at 15 lbs/M shows how much faster turf can recover with the right inputs. Faster recovery. Stronger results.


A combination of our flagship Nutri DG 18-9-18 and Nutri DG 0-0-25 fertilizers

Replenishes soil organic matter to increase nutrient uptake and water holding capacity

Superior phosphorus availability with extended release and consistent uptake regardless of soil pH
secondary and micronutrients ideal for use during greens construction
Oakville assistant superintendent volunteered at June’s U.S. Open
By Mike Jiggens
Many Canadian golf course superintendents and assistants aspire to volunteer their services at some of the PGA Tour’s more elite tournaments, including its major events. The experience is second to none, it’s a significant addition to one’s resume, and the chance to network with industry peers is invaluable.
Such was the case for Connor Brown, assistant superintendent at the Oakville Golf Club, who joined the grounds maintenance team at the Oakmont Country Club in Pennsylvania during June’s U.S. Open week.
It wasn’t Brown’s first visit to Oakmont – he did his University of Guelph internship at Oakmont last year, helping with a major renovation project – but he saw a somewhat different golf course than what he had seen previously.
“Just seeing the rough like that was crazy,” he said of the thicker and deeper turf after returning to Oakville following the June 12-15 U.S. Open. “The rest of the golf course was perfect, but it just kind of felt like it was a whole other level of perfect.”
Brown’s primary role during U.S. Open week was to mow the approaches on the

front nine holes – a task he performed both morning and evening. He also helped with bunker maintenance and positioning turning boards for the greens mowers.
Approaches were cut at a height of .220 inches which were a little higher than normal for Oakmont.
“The USGA wanted a little more defin-
ition between the green and the approaches,” Brown said. “Normally you can’t really tell the difference if you’re on the approach or on the green. That’s how tightly they’re mowed. That was the reasoning why they bumped it up.”
Brown was one of about 150 volunteers on board for tournament week, bolstering




Oakmont’s own maintenance staff of about 50 individuals. To meet the stringent agronomic demands of the USGA, work got underway early in the morning and continued into the evening, well after play had concluded for the day.
On the Monday, Tuesday and Wednesday preceding the tournament, Brown and his fellow team members arrived at the golf course about 3:30 a.m., had a quick bite to eat and then were briefed by the club superintendent about the day’s tasks before receiving their assignments.
Work began at about 4 a.m. and continued until about 7:30 or 8 o’clock when the players began their practice rounds.
Brown said the roughs were rotary hand-mowed by one team while another followed behind to “fluff” it up. Crews began their workday at the same time once the tournament started on Thursday, but would either return to their hotel after work, stay behind to watch some of the golf or converge at the maintenance shop to watch golf on television, play table tennis or hit balls into a simulator.
“During the day, you could pick what you wanted to do,” he said, noting free time could also include catching up on rest.
‘The USGA wanted a little more definition between the green and the approaches’
Following the conclusion of golf on each of the first three days, work would begin for the evening shift which ended about 9:30 or 10 o’clock. Work generally began once golfers had made the turn or were playing their last few holes.
“I napped when I could,” Brown said. “It was a long week but well worth it.”
Brown said his “coolest” experience happened on the Sunday of the tournament which marked the final round.
“When it started to rain, I thought my duties were done because there’s no evening maintenance on that day.”
While sitting in the shop and watching the golf on television, awaiting its finish, Brown said Oakmont’s assistant superintendent rushed in to tell everyone to arm themselves with squeegees.









“I got to go grab a squeegee and went up to the 18th fairway, and I was squeegeeing water off the fairway at 5:30 on the Sunday night of the final round.”
Spectators who stuck around for the rain-soaked finish to the U.S. Open cheered and applauded the grounds crew for their efforts.
“It was something I had never experienced before,” Brown said. “It was very, very cool.”
He said key takeaways from his experience included learning about Oakmont’s agronomic practices and the club’s operations. Witnessing how the club managed its staff was particularly inspiring, he said, noting he was impressed by how well crews responded to the rain.
Volunteers at the U.S. Open were afforded the opportunity to take in various seminars in between their work shifts. Topics addressed included people management which Brown said was right up his alley because it’s a key role he fills at Oakville.
The U.S. Open wasn’t Brown’s debut at volunteering at a PGA Tour event. He had previously volunteered at a Waste Management Phoenix Open tournament, recalling it “rained a bunch” at the Tour stop where it rarely rains.
“It was different than most years at the Waste Management when they have one squeegee at the property and they’re trying to figure out how to get water off the green.”

(604)

info@skynets.ca www.skynets.ca





Brown also volunteered his services a year ago at the U.S. junior amateur championship in Michigan. He said volunteering at such elite events gives him the opportunity to meet others in his profession from around the world. At June’s U.S. Open, he was partnered with an individual from Australia.
Brown said his dream is to complete the “grand slam” of volunteering at golf’s major tournaments. That leaves the Masters, PGA Championship and the Open Championship yet to fulfill.
Volunteering is hard, physical work, especially when it includes squeegeeing rain-soaked fairways and push-mowing 18 holes of five-inch rough, “but it was a lot of fun,” Brown said.
The current political climate in the United States was concerning, he said, when he first thought about crossing the border, but he said he experienced no issues.
“I was worried about it. There was another Canadian who tried to go down the week before the tournament, but he wasn’t let in.”






By Dr. Sara Stricker and Dr. Katerina Jordan
Among the many challenges facing turf managers, few are as persistent, misunderstood, and damaging as take-all patch (TAP). Caused by soil-borne fungi, this root disease silently weakens turf from below – often well before symptoms are visible at the surface. By the time the telltale patches appear on creeping bentgrass putting greens or fairways, recovery is slow, costly, and frustrating.
That’s why researchers at the Guelph Turfgrass Institute (GTI) are digging deep into the biology and management of this elusive disease – and why this work matters more than ever. With funding from the Ontario Turfgrass Research Foundation (OTRF), two projects under Dr. Katerina Jordan are underway to explore alternative control methods for take-all patch on creeping bentgrass greens.
Dr. Jordan has been researching take-all patch for nearly a decade. Turf samples submitted to the GTI diagnostics lab often show patch-like symptoms on creeping bentgrass, while neighbouring annual bluegrass remains unaffected. Under the microscope, dark “runner hyphae” can be seen colonizing the roots, even when no symptoms are visible above ground. She has observed this disease across Alberta, Saskatchewan, Manitoba, and Ontario.

TAP thrives in cool, moist conditions and is particularly aggressive in young stands of creeping bentgrass or turf that undergo frequent disruption. Unlike foliar diseases, which often respond well to timely fungicide applications, TAP attacks the root system – resulting in stunted growth, thinning turf, and increased weed invasion. The disease tends to be most severe in alkaline soils, especially those with
a pH above 7.5.
In some turfgrass systems, the severity of TAP decreases over time – a phenomenon known as take-all patch decline. This natural suppression occurs as microbial communities in the soil shift to include beneficial organisms that inhibit the pathogen. Typically observed two to five years after establishment, take-all decline has helped explain why the disease often
• Expert Techniques: Learn the latest in tree pruning and critical health & safety protocols tailored to your field.
• Real-World Insights: Engage with top industry voices offering practical advice you can put to use immediately.
• Business-Boosting Knowledge: Stay sharp and future-focused with content built to support your growth and daily operations.
Whether you’re enhancing your expertise or keeping pace with evolving standards, this event delivers hands-on value from start to finish.
Paid registration gives you full access to all sessions and expert Q&As with up to 3 Continuing Education Credits. Space is limited, so secure your spot today!

www.turfandrec.com/webinars/ arborist-summit-2025/

fades in older greens. However, Dr. Jordan has documented persistent cases of TAP on greens well beyond this expected window, suggesting there’s more to the story than just time and microbial succession.
A new pathogen identified
One method used to diagnose TAP is DNAbased pathogen testing, which detects fungal DNA directly from the rootzone. Several samples exhibiting classic TAP symptoms were recently analyzed at the University of Guelph – but surprisingly, no DNA from Gaeumannomyces graminis var.
avenae (the historically recognized pathogen) was detected.
Digging deeper, researchers used molecular diagnostics and isolation techniques to identify a different culprit: Slopeiomyces cylindrosporus. This organism (previously known as Gaeumannomyces cylindrosporus) has been known to exist as a secondary or weak pathogen of turf for quite some time, but we are seeing it emerge as a primary cause of the disease and believe that it may be playing a more prominent role in Canadian turf systems than previously believed. This is starting to reshape how scientists understand TAP’s etiology.
At the GTI, MSc student Kieran Molony is leading a multi-year study investigating how take-all patch develops under various environmental conditions and evaluating strategies for managing it. His project includes field trials, lab work, and a closer look at how factors like soil pH, microbial communities, and environmental conditions influence disease severity.
Kieran is also testing alternative control strategies, aiming to provide turf managers with options beyond conventional fungicides. To further support this work, he is collecting disease samples from turf managers across Canada, helping to map the distribution and diversity of the TAP-causing fungi. These insights will inform more targeted, effective management strategies.
Starting this fall, graduate student Efe

Engin will build on this work with a project focused on the natural decline of TAP. His research aims to gain a greater understanding of the biology of S cylindrosporus and how it differs from G avenae in the hopes of developing recommendations that may be specific to each pathogen. Efe and Kieran are also working together to identify the microbial makeup of suppressive soils –those where the disease becomes less severe without chemical inputs. By uncovering which organisms are responsible for this suppression and under which conditions they tend to thrive, Efe and Kieran hope to lay the foundation for biological control approaches to managing TAP. Efe will also delve into investigating creeping bentgrass cultivar susceptibility in the hopes of helping turf managers make better-informed decisions when selecting grasses for new greens or renovation projects.
Together, this growing body of research aims to deliver more sustainable solutions, including non-fungicide control options and improved cultivar selection, that reduce the long-term impact of take-all patch in Canadian turf systems.
Those wishing to learn more were at the Guelph Turfgrass Institute on Aug. 20 for GTI Field Day. Attendees got an up-close look at take-all patch trials and heard directly from the researchers leading this important work.
While there’s no silver bullet for managing TAP, every study brings us closer to stronger, healthier, more resilient turf. In the fight against below-ground disease, knowledge is our most powerful tool.
If you are a Canadian turfgrass manager and would like to submit a turf sample you suspect is affected by take-all patch, visit www.guelphturfgrass.ca/TAP2025 for submission details. Stay connected with GTI by signing up for the newsletter at www.GuelphTurfgrass.ca or following us on social media @GuelphTurf.






Weather events and natural disasters are becoming more frequent and more severe. The number of extreme fires has increased by seven times in the past 20 years in Canada and more than 10 times in the United States. Flooding is the No. 1 natural disaster in Canada – more common than earthquakes, tornadoes, and even wildfires. And the risk of flooding is expected to continue to grow in the coming decades.
The economic impact of these events is huge. The Institute for Catastrophic Loss Reduction found that, in 2023, Canada experienced almost $7 billion in direct damage from floods, wildfires, tornadoes, and other extreme events – compare that to 40 years ago, when the damage was estimated at $30 million. And that $7-billion figure doesn’t include lost revenue experienced by businesses as they attempt to get up and running again after a disaster.
In an era of escalating events like floods, wildfires, windstorms, and droughts – or
even extreme temperature fluctuations –landscaping and turf professionals are increasingly finding themselves on the front lines of disaster response and preparation. From repairing storm-ravaged municipal parks to fire-proofing green spaces, the demands on crews have never been higher or more unpredictable.
In late March 2025, Ontario and Quebec experienced a severe ice storm, causing $342 million in insured damage. More than one million homes and businesses in Ontario and around 70,000 properties in Quebec experienced power outages. In some cases, communities were without electricity for more than a week due to strong winds and heavy rainfall that prevented crews from completing necessary work. Then, in June, a massive windstorm hit the Algonquin Park area in Ontario, downing trees and flattening areas with downbursts.
After major storms like these, the land-
scape isn’t just messy – it’s unstable. One wrong step or unexpected gust can send a weakened trunk crashing down, potentially injuring workers or bringing down critical infrastructure like power lines. Traditional methods – climbing trees with chainsaws or using bucket trucks in rough terrain –only increase the danger.
That’s why cleanup crews are getting smarter – and safer – about how they work. Across the hardest-hit regions, operators are adopting new strategies and equipment to reduce risk and get the job done faster. Telehandlers and cranes fitted with mechanical saw heads allow crews to dismantle dangerous trees from the ground, piece by piece, without putting workers in danger. Instead of sending climbers into compromised canopies, operators stay safely on the ground or inside a protected cab while the equipment handles the heavy lifting – literally. They then use stump grinders, woodchippers, and brush cutters to clear debris from the ground.
“It’s a game-changer,” Brandt director of sales, underground and tree care, Stewart

For more than a decade, the Color Atlas ofTurfgrassWeeds has been the leading authority for green industry professionals in their ongoing quest to control weeds and limit deleterious effects: the weed clumps, color variation, and unsightly patches that disrupt turf uniformity. The Second Edition of this essential resource has been expanded and updated to provide control information that professionals need to maintain the quality that is so vital to the golf, sports field, and managed landscape industries.
| Item#0470189511



Hunt says. “You’re keeping your people out of harm’s way while increasing your efficiency. In situations like these, that’s everything.”
Golf courses and parks sustained huge amounts of damage during the ice and wind storms. To clean up recreational areas, crews use stump grinders and mulching forestry mowers to ensure the ground is free of tripping hazards for the public.
“Something like a park needs to be brought back to an urbanized setting to be safe for people to walk through again,” Hunt explains.
Now that the immediate danger is over, crews have transitioned to a preventative approach.
“They’re clearing 10 metres across the roadways – five metres from the centre of the road to each ditch line – and taking everything out, so trees won’t have a chance to fall and hit the road the next time there’s a storm,” Hunt says.
Prevention extends beyond avoiding the dangers of falling trees. If downed wood isn’t removed from treed areas, it can become a fuel source for wildfires.
“So, there’s a snowball effect that’s possible,” Hunt says. “With hot, dry summers, treetops and limbs broken by storms can fall and become dried out, which makes them more combustible.”
Wildfires have become increasingly more
common across North America and around the world. And they don’t just occur in forests or grasslands – you’ll also find them in urban yards and on commercial properties. As a result, landscaping experts are increasingly finding themselves at the forefront of fire prevention initiatives. Firewise USA, a program of National Fire Protection Association (NFPA), provides simple, effective steps to help professionals and communities reduce the risk of destruction from wildfire. Some of these include:
• Clearing ignitable material, such as needles and leaves, from roof, gutter, eaves, porches and decks
• Replacing mulch with hardscaping, including rock, gravel, or stone
• Protecting by watering dry grass and shrubs, trimming brown vegetation, and disposing of yard waste
• Pruning low-hanging branches (six to 10 feet for taller trees, one-third of tree height for smaller trees) and removing any tall grasses, vines, and shrubs from under trees
The “home ignition zone” includes the home at the centre and the area within 100 feet of it. By keeping everything irrigated with low-growing and low-flammable plants; creating separation between grasses, shrubs, and trees; and spacing trees to prevent crowns from touching, you can avoid fire spreading into taller vegetation in a “fuel ladder” effect. Research shows that keeping high-intensity fires 100 feet from a home will prevent the fire from igniting the
home directly. Beyond the 100-foot zone, you can further prevent damage by using low-growing plants and well-spaced trees and keeping the volume of vegetation –or fuel – low.
Landscaping professionals can also play a major role in preventing flooding in urban areas. For example, Hoboken, N.J., experiences flood risks related to storm surge and rainfall due to both hurricane events and more frequent, heavy rainfalls which cause damage throughout the city. In the years following Hurricane Sandy in 2012, the city acted on its vision for resiliency parks, an innovative combination of above-ground recreational amenities and green infrastructure and below-ground gray infrastructure.
As the frequency and intensity of extreme weather events and natural disasters continue to rise, the role of landscaping and turf professionals has become more critical than ever. They’re not only tasked with the challenging and often dangerous job of cleaning up after storms, fires, and floods but are also increasingly focused on proactive measures to mitigate future risks. Dedication and ingenuity are essential in protecting communities and keeping green spaces safe. Sabrina Cataldo is a senior copywriter with the Brandt Group of Companies.



There are several things to consider when looking for what’s needed. By Joel Hicks
Shopping for a new tractor? It’s a big investment that can have a lasting impact on how efficiently and effectively you get the job done. Whether you’re maintaining a sports field, managing a public park, or handling grounds care on a private estate, the right machine makes all the difference.
Tractors are more versatile than ever, handling everything from turf care and material transport to seasonal tasks, like leaf cleanup and snow removal. With the off season approaching, now’s the perfect time to take stock of your needs and find a machine that fits your workload.
Consider these key factors to help you find the tractor that works best for you.
The right tractor for you depends on your day-to-day tasks. Start by thinking about how much land you manage and the kind of jobs you handle most often. Also consider whether your needs might grow over time – such as adding hardscape features, like pathways or retaining walls, or expanding your services to include commercial mowing or seasonal cleanup.
• Sub-compact tractors are ideal for properties under five acres and navigat-
ing tight spaces; perfect for mowing, light landscaping, and leaf removal.
• Compact tractors suit properties up to 20 acres, offering a balance of power and maneuverability for aeration, topdressing, and light hauling.
• Utility tractors are ideal for properties more than 20 acres, where heavy hauling, snow removal, or large-scale maintenance are routine.
Matching the right machine to your workload not only boosts efficiency, but it can also extend the life of your equipment. By understanding your typical workload and the space you’re working in, you can decide on the machine that’s the best fit.
Tractors come in all shapes, sizes, and price points. Before you decide, set a budget and decide whether buying new or used is right for you.
Used tractors can be a smart choice if you’re looking to save upfront, especially if you plan to pay in full without financing. Just be sure to do your homework. Check the machine’s service history, ask your dealer about expected maintenance costs, and speak with other owners about their experi-
ences.
New tractors typically cost more, but often come with valuable benefits, like warranty coverage, financing options, and the latest features. If you’re preparing for a busy season and want a reliable, long-term solution, new equipment might offer greater peace of mind.
Whichever route you choose, make sure the tractor fits both your workload and your wallet.
Horsepower and price are important, but there’s more to the whole story. The right features can make your tractor more productive, more comfortable, and easier to maintain, especially if you’re using it regularly or in tough conditions.
Choosing features that match your environment and workload will pay off in the long run. Consider what will make your daily tasks smoother.
Cabs with heat and A/C extend your work hours and keep you comfortable in all kinds of weather. Ergonomically placed controls, suspension seats, and clear cat visibility reduce fatigue and improve efficiency, particularly on long days of mowing or hauling.
Tires with good traction are essential when operating your machine on soggy or
uneven ground. This is especially vital when pulling aerators or hauling mulch and compost. A versatile PTO and hydraulic system allow you to use any attachment that you need and switch it out easily.
Depending on how often you use your machine, your maintenance schedule can vary. Accessible service points can save time and effort if you handle your own maintenance.
Selecting features that fit your environment and daily demands isn’t just about
convenience, they’re about protecting your investment, getting more done, and making each workday more productive.
Depending on your regular tasks, you might need to equip your tractor with different attachments. A tractor is only as useful as the tools it can use.
When buying a new tractor, consider which attachments you need and what machines are compatible with them.
Prioritize the attachments you will use most often and think about how easily they can be switched out. A tractor that supports multiple attachments and allows for quick changes can save you a lot of time and hassle.
A tractor is a major investment, but with a little planning and the right questions, you can find a machine that works as hard as you do.
Joel Hicks is product line manager (tractor) for KIOTI Tractor.

The turf and grounds maintenance industry has been male dominated since its early beginnings. As such, personal protection equipment and workwear has traditionally been designed with the male worker in mind.
With women entering the industry over the years, they have typically donned men’s workwear, albeit in smaller sizes. While this may work out in a pinch, it’s far from being a suitable long-term solution.
“The biggest gap is proper fit,” says Sarah Bletcher, product manager for jobsite apparel at Milwaukee Tool®. “Many women still end up wearing scaled down versions of men’s clothing. These often don’t accommodate differences in body shapes – those narrower shoulders, their shorter torso and wider hips. This leads to discomfort and restricted movement and makes it harder for these women to work efficiently and safely.”
Milwaukee Tool recognized the market gap and launched its women’s workwear line following extensive research, knowing there was a trend emerging as more women were entering into the skilled trades, including landscaping.
“Less than five per cent of women’s apparel in the market today is trade focused,” Bletcher says, adding less than 20 per cent of major workwear destinations carry only a single women’s style. Milwaukee Tool saw that as an opportunity to make significant strides in the market.
Bletcher highlights several of the traditional brands had only variations in colours available instead of styles that were more practical for women. Pants that

didn’t fit properly at the waist or hips presented a challenge for women while shirts tended to be too “boxy” or too long and lacked a tapered-off design. There were also issues with garments that weren’t breathable and lacked proper sun protection.“It’s not durable enough to hold up in these tough conditions,” she remarks. Milwaukee Tool has a WORKSKIN collection that is built to fight sweat and is suitable for both hot and cold conditions. This lineup is focused on moisture management, breathability, and lightweight material. There are eight distinct styles within the collection – the most popular hot weather garment being the hooded sun shirt made from 100 per cent polyester, odour-fighting fabric and UPF 50+ sun protection. On the cold weather side, Milwaukee Tool has a crew neck base-layer shirt engineered with a custom sweat-wicking fabric and a brushed fleece interior that keeps one dry and warm.
Bletcher emphasizes that workwear plays a bigger role in workplace equity that many don’t realize, especially in trades that are traditionally male dominated.
“When women have access to gear that fits, functions and performs just as well as men’s, it sends a powerful message that they belong and feel valued on the job,” she says.












A.R. MOWER & SUPPLY
3 - 7167 Vantage Way
Delta BC V4G 1K7
Tel: 604-940-1011
Toll free: 800-667-4211
e-mail: orders@armower.com Website: armower.com
ACTION SUPPLIES INC.
51 Observatory Ln
Richmond Hill ON L4C 8K9
Tel: 647-227-1357
e-mail: info@actionsupplies.ca Website: actionsupplies.ca
ASM PEST CONTROL
15581 89 Ave
Surrey BC V3R 0R3
Tel: 604-589-5403
e-mail: asmpestcontrol@gmail.com
Website: asmpestcontrol.com
BELCHIM TURF PROTECTION
CANADA
104 Cooper Dr., Unit 3
Guelph ON N1C 0A4
Tel: 519-826-7878
Toll free: 866-613-3336
Fax: 519-826-7675
e-mail: barry.johnson@belchim.com Website: belchimturf.ca
BUFFALO TURBINE
180 Zoar Valley Road
Springville NY 14141
Tel: 716-592-2700
e-mail: btsales@buffaloturbine.com Website: buffaloturbine.com
BUILTRIGHT
131 Continental Drive
Newark DE 19713
Tel: 470-264-9485
e-mail: team@builtright.com
Website: builtright.co
CANADASALT GROUP LTD
10638 9th Line, Markham, ON Markham BC L6B 1A8
Tel: 866-321-7258
e-mail: sales@canadasalt.ca
Website: canadasalt.ca

CUB CADET
Tel: 800-668-1238
Toll free: 800-668-1238
Fax: 800-668-6677
e-mail: kevindunbar@cubcadet.com
Website: cubcadet.ca
DIAMOND MOWERS
350 East 60th St. N.
Sioux Falls SD 57104
Tel: 605-977-3300
e-mail: info@diamondmowers.com
Website: diamondmowers.com
DR MOWER PARTS
5-1304-44 Ave NE Calgary AB T2E 6L6
Tel: 587-329-6642
Toll free: 877-531-2873
e-mail: parts@drmower.ca
Website: drmower.ca

FIBRAMULCH
29 Killaloe Rd, Unit 2
CONCORD ON L4K 2A8
Tel: 905-761-6969
Website: fibramulch.com
Description: For almost 50 years, FIBRAMULCH has delivered knowledgeable advice, service, rentals and products for Erosion Control, Sediment Control & Land Reclamation. Proud partners of DLF, LSC, Profile, FINN, ABI & TurfTeq. We’re your one-stopshop—call us today!
GRANTS SMALL MOTORS INC
7865 A East Saanich Rd
Saanichton BC V8M 2B4
Tel: 250-656-7714
e-mail: rim4shot@gmail.com
Website: grantssmallmotors.ca
GREENWORKS TOOLS CANADA
67 Toll Rd
Holland Landing ON L9N 1H2
Tel: 416-859-9878
e-mail: gwcanadaprograms@ greenworkstools.com
HERITAGE TREE SERVICE
4333 West 16th Ave, Vancouver, BC V6R 3E6
Tel: 604-762-6538
e-mail: heritagetreeservice@outlook.com Website: heritagetreeservice.ca
JCL AG SERVICES INC.
4091 Seldon Road
Abbotsford BC V2S 7T4
Tel: 604-855-1241
e-mail: jclagservices@gmail.com Website: jclturfservices.ca
JCL AG SERVICES INC./ MAREDO
4091 Seldon Rd
Abbotsford BC V2S 7T4
Tel: 604-855-1241
e-mail: patdiffer@gmail.com Website: maredo-bv.com
LAVINGTON TURF FARMS
5770 Petworth Rd
Coldstream BC V1B 3E4
Tel: 250-549-2967
e-mail: lavingtonturf@gmail.com Website: lavingtonturf.com
MAKITA CANADA INC.
1950 Forbes Street
Whitby ON L1N 7B7
Tel: 905-809-0152
Toll free: 800-263-3734
e-mail: s.ottewell@makita.ca Website: makita.ca
MARMIC SOLUTIONS
795 Rathbourne Ave
Woodstock ON N4S 4L8
Tel: 519-421-6783
e-mail: mkean@mjkean.com Website: marmicsolutions.com
MECALAC NORTH AMERICA
282 Dedham Street
Norfolk MA 02056
Tel: 508-921-3076
e-mail: mecalac.
northamerica@mecalac.com
Website: mecalac.com/en
MINROCK TECHNOLOGIES INC.
PO. Box 1522, Woodstock
Station Main
Woodstock ON N4S 0A7
Tel: 519-421-6783
e-mail: mkean@mjkean.com
Website: minrocktechnologies.com
NUTRIEN SOLUTIONS | EVERGRO DIVISION
7430 Hopcott Rd.
Delta BC V4G 1B6
Tel: 604-940-0290
Toll free: 800-663-2552
Fax: 604-940-0258
e-mail: evergro@nutrien.com
Website: nutrienagsolutions.ca
OAKCREEK GOLF & TURF
15 - 4970 Polkey Road
Duncan BC V9L 6W3
Tel: 250-701-0766
Toll free: 888-773-7335
Fax: 250-701-0767
e-mail: nagyd@oakcreekgolf. com
Website: oakcreekgolf.com
OAKCREEK GOLF & TURF
150 - 1735 Dolphin Avenue
Kelowna BC V1Y 8A6
Tel: 250-860-5090
Toll free: 888-773-7335
Fax: 250-860-5037
e-mail: daviesk@oakcreekgolf.com Website: oakcreekgolf.com
OAKCREEK GOLF & TURF
18785 96th Avenue
Surrey BC V4N 3P5
Tel: 604-882-8399
Toll free: 888-773-7335
Fax: 604-882-8721
e-mail: bluec@oakcreekgolf.com
Website: oakcreekgolf.com
PILGRIM PEST PROFESSIONALS
26 Palmer Rd Plymouth MA 02360
Tel: 508-208-3864
e-mail: marketing@ pilgrimpestpro.com
Website: pilgrimpestpro.com/ pest-control
Willowbrook Business Centre, Unit 114, 19292 60th Avenue
Surrey BC V3S 3M2
Tel: 604-539-8744
Toll free: 800-387-2449
e-mail: langleyhub@ plantproducts.com
Website: plantproducts.com
Description: Full line distributor of pest control, fertilizer and other consumable goods. Trusted partner in the industry for over 75 years.
PREMIER PACIFIC SEEDS
LTD
#203, 19315 96 Ave
Surrey BC V4N4C4
Tel: 604-881-1323
e-mail: info@ premierpacificseeds.com
Website: premierpacificseeds.com
RAIN BIRD CORPORATION
6991 East Southpoint Road
Tucson AZ 85756
Tel: 587-575-5775
e-mail: dzabel@rainbird.com Website: rainbird.com
REDDEN NET CUSTOM
NETS LTD.
5620 198th St.
Langley BC V3A 7C7
Tel: 604-530-2213
Toll free: 800-667-9455
Fax: 604-530-2218
e-mail: info@redden-net.com Website: redden-net.com
ROBERT KAINS GOLF COURSE DESIGN LTD.
3671 Seashell Place
Victoria BC V9C 0A4
Tel: 403-678-8482
e-mail: kains@kainsgolfdesign.com Website: kainsgolfdesign.com
SKY LINE NET
INSTALLATIONS INC.
21458 24th Ave.
Langley BC V2Z 2A8
Tel: 604-328-1474
e-mail: greg@skynets.ca Website: skynets.ca
TALBERT MANUFACTURING
1628 W. State Road 114
Rensselaer IN 47978
Tel: 800-348-5232
e-mail: sales@talbertmfg.com
Website: talbertmfg.com
TAYLOR’S TURF CARE PRODUCTS
#203 – 19315 96th Avenue
Surrey BC V4N 4C4
Tel: 604-552-3960
e-mail:
info@taylorsturfcare.com Website: taylorsturfcare.com
TROJAN BATTERY COMPANY
12380 Clark Street
Santa Fe Springs CA 90670
Tel: 800-423-6569
e-mail: technical@ trojanbattery.com Website: trojanbattery.com

WATERKIND CONSULTING SERVICES LTD.
3990 Eastwood Drive
Kelowna BC V1W4E8
Tel: 250-826-5463
Website: waterkind.ca
Description: Waterkind is your irrigation efficiency
partner. With over 60 years of experience, we specialize in high efficiency designs, certified audits & assessments, consulting and timely and relevant insights to strategically improve your irrigation systems. www.waterkind.ca waterkindinfo@gmail.com
WESTERRA EQUIPMENT
3349 Mt. Lehman Rd
Abbotsford BC V2T 5M1
Tel: 888-713-4748
e-mail: marketing@ westerraequipment.com
Website: westerraequipment.com
AERATION/OVERSEEDING SERVICE
FIBRAMULCH
JCL AG SERVICES INC./ MAREDO OAKCREEK GOLF & TURF
AERATORS - SOIL FIBRAMULCH
JCL AG SERVICES INC./ MAREDO OAKCREEK GOLF & TURF

turfandrec.com
AERATORS - WATER
OAKCREEK GOLF & TURF
ARCHITECTS, SPORTS FIELDS
REDDEN NET CUSTOM NETS LTD. SKY LINE NET INSTALLATIONS INC.
ARCHITECTS/CONTRACTORS, GOLF COURSE
REDDEN NET CUSTOM NETS LTD.
ROBERT KAINS GOLF COURSE DESIGN LTD.
SKY LINE NET INSTALLATIONS INC.
BALL DIAMOND GREEN FIBRAMULCH
BLOWER TRUCK OR MATERIAL
BLOWER FIBRAMULCH
BUNKER MAINTENANCE
OAKCREEK GOLF & TURF PLANT PRODUCTS
BUSINESS SOFTWARE BUILTRIGHT
CHEMICALS
BELCHIM TURF PROTECTION CANADA
NUTRIEN SOLUTIONS | EVERGRO DIVISION
PLANT PRODUCTS
CONSULTING
SKY LINE NET INSTALLATIONS INC.
WATERKIND CONSULTING SERVICES LTD.
EARTHMOVING EQUIPMENT
DIAMOND MOWERS
MECALAC NORTH AMERICA
WESTERRA EQUIPMENT
ENGINES
OAKCREEK GOLF & TURF
EQUIPMENT PARTS
DR MOWER PARTS
FIBRAMULCH
EQUIPMENT RENTALS
DIAMOND MOWERS
FIBRAMULCH
JCL AG SERVICES INC./ MAREDO
EROSION CONTROL
FIBRAMULCH
PREMIER PACIFIC SEEDS LTD
FENCING
FIBRAMULCH
REDDEN NET CUSTOM NETS LTD.
SKY LINE NET INSTALLATIONS INC.
FERTILIZER
FIBRAMULCH
MARMIC SOLUTIONS
MINROCK TECHNOLOGIES INC.
NUTRIEN SOLUTIONS | EVERGRO DIVISION
PLANT PRODUCTS
TAYLOR’S TURF CARE PRODUCTS
GOLF COURSE ACCESSORIES
PLANT PRODUCTS
REDDEN NET CUSTOM NETS LTD.
GROOMERS, GOLF
OAKCREEK GOLF & TURF
GROOMERS, SPORT TURF
FIBRAMULCH
OAKCREEK GOLF & TURF
GROWTH ENHANCERS
BELCHIM TURF PROTECTION CANADA
FIBRAMULCH
MARMIC SOLUTIONS
PLANT PRODUCTS
HYDROSEEDING
FIBRAMULCH
INSECT/MOSQUITO CONTROL
ASM PEST CONTROL
PILGRIM PEST PROFESSIONALS
PLANT PRODUCTS
IRRIGATION
OAKCREEK GOLF & TURF
RAIN BIRD CORPORATION
WATERKIND CONSULTING SERVICES LTD.
LAKE/POND MANAGEMENT
MINROCK TECHNOLOGIES INC.
OAKCREEK GOLF & TURF
PLANT PRODUCTS
TAYLOR’S TURF CARE PRODUCTS
LANDSCAPING EQUIPMENT, HANDHELD (BATTERY)
GRANTS SMALL MOTORS INC
GREENWORKS TOOLS CANADA
TROJAN BATTERY COMPANY
LANDSCAPING EQUIPMENT, HANDHELD (GAS)
FIBRAMULCH
WESTERRA EQUIPMENT
LANDSCAPING SUPPLIES/MATERIALS
ACTION SUPPLIES INC.
FIBRAMULCH
PLANT PRODUCTS
TROJAN BATTERY COMPANY
LIGHTING
MAKITA CANADA INC.
MOWERS (BATTERY-POWERED)
GREENWORKS TOOLS CANADA
MOWERS (GANG AND ATTACHMENTS)
DIAMOND MOWERS
MOWERS, GOLF
A.R. MOWER & SUPPLY
CUB CADET
GREENWORKS TOOLS CANADA
MAKITA CANADA INC.
OAKCREEK GOLF & TURF
MOWERS, LANDSCAPING
A.R. MOWER & SUPPLY
CUB CADET
GREENWORKS TOOLS CANADA
OAKCREEK GOLF & TURF
MULCH
FIBRAMULCH
TAYLOR’S TURF CARE PRODUCTS
NETTING/FENCING
FIBRAMULCH
REDDEN NET CUSTOM NETS LTD.
SKY LINE NET INSTALLATIONS INC.
PEAT
PLANT PRODUCTS
PIPING, GOLF COURSE
OAKCREEK GOLF & TURF
PUMPS/PUMPING STATIONS
OAKCREEK GOLF & TURF
RAIN BIRD CORPORATION
REEL GRINDING EQUIPMENT
OAKCREEK GOLF & TURF
SEED
FIBRAMULCH
NUTRIEN SOLUTIONS | EVERGRO DIVISION
PLANT PRODUCTS
PREMIER PACIFIC SEEDS LTD
TAYLOR’S TURF CARE PRODUCTS
SEEDERS
FIBRAMULCH
JCL AG SERVICES INC./ MAREDO
OAKCREEK GOLF & TURF
TAYLOR’S TURF CARE PRODUCTS
SNOW REMOVAL EQUIPMENT/ BLOWERS
FIBRAMULCH
GREENWORKS TOOLS CANADA
SNOW/ICE REMOVAL, SALT/DE-ICERS
CANADASALT GROUP LTD
CUB CADET
MECALAC NORTH AMERICA
OAKCREEK GOLF & TURF
PLANT PRODUCTS
TAYLOR’S TURF CARE PRODUCTS
SOIL ANALYSIS
PLANT PRODUCTS
SOIL CONDITIONERS/AMENDMENTS/ MIXTURES
BELCHIM TURF PROTECTION CANADA
FIBRAMULCH
MARMIC SOLUTIONS
MINROCK TECHNOLOGIES INC.
PLANT PRODUCTS
TAYLOR’S TURF CARE PRODUCTS
SOIL PREPARATION
FIBRAMULCH
SPORT CLAY PRODUCTS
PLANT PRODUCTS
SPRAYERS
FIBRAMULCH
TAYLOR’S TURF CARE PRODUCTS
SPREADERS
CUB CADET
OAKCREEK GOLF & TURF
TAYLOR’S TURF CARE PRODUCTS
SYNTHETIC TURF SUPPLIES/ EQUIPMENT
OAKCREEK GOLF & TURF
TOPDRESSING MATERIALS/ EQUIPMENT
FIBRAMULCH
OAKCREEK GOLF & TURF
PLANT PRODUCTS
TRAILERS
TALBERT MANUFACTURING
TREE CARE EQUIPMENT
DIAMOND MOWERS
MAKITA CANADA INC.
PLANT PRODUCTS
WESTERRA EQUIPMENT
TREE CARE SERVICE
HERITAGE TREE SERVICE
TREE CARE SUPPLIES
PLANT PRODUCTS
ACTION SUPPLIES INC.
51 Observatory Ln
Richmond Hill ON L4C 8K9
Tel: 647-227-1357
e-mail: info@actionsupplies.ca Website: actionsupplies.ca
ARCTIC TURF SHIELD
PO 64289 RPO Wye Road
Sherwood Park AB T8B 0A5
Tel: 877-272-8420
e-mail: info@arcticturfshield.ca Website: arcticturfshield.ca
BELCHIM TURF PROTECTION
CANADA
104 Cooper Dr., Unit 3 Guelph ON N1C 0A4
Tel: 519-826-7878
Toll free: 866-613-3336
Fax: 519-826-7675
e-mail: barry.johnson@belchim.com Website: belchimturf.ca
BUFFALO TURBINE
180 Zoar Valley Road
Springville NY 14141
Tel: 716-592-2700
e-mail: btsales@buffaloturbine.com Website: buffaloturbine.com
BUILTRIGHT
131 Continental Drive
Newark DE 19713
Tel: 470-264-9485
e-mail: team@builtright.com
Website: builtright.co
CANADASALT GROUP LTD
10638 9th Line, Markham, ON Markham BC L6B 1A8
Tel: 866-321-7258
e-mail: sales@canadasalt.ca Website: canadasalt.ca
CANADIAN ROCK SIGNS LTD.
4527 - 48 Ave.
Lacombe AB T4L 2C1
Tel: 403-782-4883
Toll free: 800-463-7446
e-mail: info@rocksigns.ca
Website: rocksigns.ca
TURF CARE ACCESSORIES
BELCHIM TURF PROTECTION CANADA
FIBRAMULCH
PLANT PRODUCTS
TAYLOR’S TURF CARE PRODUCTS
TROJAN BATTERY COMPANY
TURF POWER EQUIPMENT
A.R. MOWER & SUPPLY
BUFFALO TURBINE
CUB CADET
FIBRAMULCH
JCL AG SERVICES INC.
JCL AG SERVICES INC./ MAREDO
MAKITA CANADA INC.
MECALAC NORTH AMERICA
OAKCREEK GOLF & TURF
TROJAN BATTERY COMPANY
WESTERRA EQUIPMENT
9523 - 41 Ave.
Edmonton AB T6E 5X7
Tel: 780-436-5894
Fax: 780-463-0674
e-mail: merrill@carlyleandcompany.ca Website: carlyleandcompany.ca
CUB CADET
Tel: 800-668-1238
Toll free: 800-668-1238
Fax: 800-668-6677
e-mail: kevindunbar@cubcadet.com Website: cubcadet.ca
DR MOWER PARTS
5-1304-44 Ave NE
Calgary AB T2E 6L6
Tel: 587-329-6642
Toll free: 877-531-2873
e-mail: parts@drmower.ca Website: drmower.ca

FIBRAMULCH
29 Killaloe Rd, Unit 2
CONCORD ON L4K 2A8
Tel: 905-761-6969
Website: fibramulch.com
Description: For almost 50 years, FIBRAMULCH has delivered knowledgeable advice, service, rentals and products for Erosion Control, Sediment Control & Land Reclamation. Proud partners of DLF, LSC, Profile, FINN, ABI & TurfTeq. We’re your one-stopshop—call us today!
TURF TIRES
CUB CADET
LAVINGTON TURF FARMS
OAKCREEK GOLF & TURF
VACUUMS
MAKITA CANADA INC.
OAKCREEK GOLF & TURF
WEATHER MONITORING
OAKCREEK GOLF & TURF
WETTING AGENTS
FIBRAMULCH
MARMIC SOLUTIONS
PLANT PRODUCTS
TAYLOR’S TURF CARE PRODUCTS
GREENJACKET SPORT TURF COVERS
PO Box 310, 218 South Rd. Genoa City WI 53128
Tel: 888-786-2683
Fax: 262-279-6744
e-mail: info@greenjacket.com
Website: greenjacket.com
GREENWORKS TOOLS CANADA
67 Toll Rd
Holland Landing ON L9N 1H2
Tel: 416-859-9878
e-mail: gwcanadaprograms@ greenworkstools.com

HORIZON AG & TURF CALGARY
11184 42 Street SE
Calgary AB T2C 0J9
Tel: 403-253-6187
Toll free: 877-627-8468
e-mail: md@martindeerline.com
Website: horizonagturf.com
Description: At Horizon Ag & Turf, we’re committed to providing unbeatable service and support throughout the life of the product. We understand it’s not a 9-5 job, that’s why you can trust Horizon Ag & Turf to be part of your team. We’re proud to carry quality products from suppliers such as John Deere, Agrimetal, Buffalo, Dakota, Foley, Lastec, Lely, Steiner, TruTurf, Wiedenmann and more!

HORIZON AG & TURF WEST
EDMONTON
17104 - 118 Avenue
Edmonton AB T5S 2L7
Tel: 780-452-2790
Toll free: 877-627-8468
Fax: 780-451-2678
e-mail: md@martindeerline.com
Website: horizonagturf.com
Description: At Horizon Ag & Turf, we’re committed to providing unbeatable service and support throughout the life of the product. We understand it’s not a 9-5 job, that’s why you can trust Horizon Ag & Turf to be part of your team. We’re proud to carry quality products from suppliers such as John Deere, Agrimetal, Buffalo, Dakota, Foley, Lastec, Lely, Steiner, TruTurf, Wiedenmann and more!
MAKITA CANADA INC.
1950 Forbes Street
Whitby ON L1N 7B7
Tel: 905-809-0152
Toll free: 800-263-3734
e-mail: s.ottewell@makita.ca
Website: makita.ca
MARMIC SOLUTIONS
795 Rathbourne Ave
Woodstock ON N4S 4L8
Tel: 519-421-6783
e-mail: mkean@mjkean.com
Website: marmicsolutions.com
MCL CONTRACTING - LANDSCAPING CHRISTCHURCH
412 Weedons Ross Road, West Melton, Christchurch 7675, New Zealand West Melton KS 7675
Tel: 033478555
e-mail: landscaperchristchurch@gmail. com
Website: mclcontracting.co.nz/service/ landscaping-christchurch
MECALAC NORTH AMERICA
282 Dedham Street
Norfolk MA 02056
Tel: 508-921-3076
e-mail: mecalac.northamerica@mecalac. com
Website: mecalac.com/en
MINROCK TECHNOLOGIES INC.
PO. Box 1522, Woodstock Station Main Woodstock ON N4S 0A7
Tel: 519-421-6783
e-mail: mkean@mjkean.com
Website: minrocktechnologies.com
NUTRIEN SOLUTIONS | EVERGRO DIVISION
285243 Frontier Road Unit 1
Rocky View County AB 1X 0N2
Tel: 403-287-3988
Toll free: 800-661-2991
Fax: 403-243-7470
e-mail: evergro@nutrien.com Website: nutrienagsolutions.ca
OAKCREEK GOLF & TURF
8220 Davies Road
Edmonton AB T6E 4N2
Tel: 780-463-2332
Toll free: 888-773-7335
Fax: 780-466-2998
e-mail: loughk@oakcreekgolf.com Website: oakcreekgolf.com
OAKCREEK GOLF & TURF
3816 - 64 Avenue SE
Calgary AB T2C 2B4
Tel: 403-279-2907
Toll free: 888-773-7335
Fax: 403-236-7995
e-mail: balmerj@oakcreekgolf.com Website: oakcreekgolf.com
PILGRIM PEST PROFESSIONALS
26 Palmer Rd
Plymouth MA 02360
Tel: 508-208-3864
e-mail: marketing@pilgrimpestpro.com Website: pilgrimpestpro.com/pest-control
RAIN BIRD CORPORATION
6991 East Southpoint Road
Tucson AZ 85756
Tel: 587-575-5775
e-mail: dzabel@rainbird.com Website: rainbird.com
REDDEN NET CUSTOM NETS LTD.
5620 198th St.
Langley BC V3A 7C7
Tel: 604-530-2213
Toll free: 800-667-9455
Fax: 604-530-2218
e-mail: info@redden-net.com Website: redden-net.com
ROBERT KAINS GOLF COURSE DESIGN LTD.
3671 Seashell Place
Victoria BC V9C 0A4
Tel: 403-678-8482
e-mail: kains@kainsgolfdesign.com Website: kainsgolfdesign.com
SKY LINE NET INSTALLATIONS INC.
21458 24th Ave.
Langley BC V2Z 2A8
Tel: 604-328-1474
e-mail: greg@skynets.ca Website: skynets.ca
TALBERT MANUFACTURING
1628 W. State Road 114
Rensselaer IN 47978
Tel: 800-348-5232
e-mail: sales@talbertmfg.com Website: talbertmfg.com
TROJAN BATTERY COMPANY
12380 Clark Street
Santa Fe Springs CA 90670
Tel: 800-423-6569
e-mail: technical@trojanbattery.com Website: trojanbattery.com
WALLAH SIGNS
4948 - 54th Avenue
Red Deer AB T4N 5K8
Tel: 403-343-1672
Toll free: 800-909-9927
e-mail: golfsales@wallah signs.com
Website: wallahsigns.com

WOOD BAY TURF TECHNOLOGIES
202 - 8704 51 Ave.
Edmonton AB T6E 5E8
Tel: 780-468-4378
Toll free: 800-661-4942
Fax: 780-468-0059
e-mail: info@woodbayturftech.com
Website: woodbayturftech.com
Description: Wood Bay is a Family Owned Business, in operation since 1987. See our line of outstanding turf care and maintenance products, including our greensIRON 3900 turf rollers, our fds9200 multipurpose turf dethatcher and dynaBLADE our famous tungsten carbide tipped vertical cutting blade, precisely engineered and manufactured to meet the requirements of all major manufacturers’ verticut/mower machines.
AERATION/OVERSEEDING SERVICE
FIBRAMULCH
OAKCREEK GOLF & TURF
WOOD BAY TURF TECHNOLOGIES
AERATORS - SOIL
FIBRAMULCH
HORIZON AG & TURF CALGARY
HORIZON AG & TURF WEST EDMONTON
OAKCREEK GOLF & TURF
WOOD BAY TURF TECHNOLOGIES
AERATORS - WATER
OAKCREEK GOLF & TURF
ARCHITECTS, SPORTS FIELDS
GREENJACKET SPORT TURF COVERS
REDDEN NET CUSTOM NETS LTD. SKY LINE NET INSTALLATIONS INC.
ARCHITECTS/CONTRACTORS, GOLF COURSE
REDDEN NET CUSTOM NETS LTD.
ROBERT KAINS GOLF COURSE DESIGN LTD.
SKY LINE NET INSTALLATIONS INC.
BALL DIAMOND GREEN FIBRAMULCH
BLOWER TRUCK OR MATERIAL
BLOWER FIBRAMULCH
BUNKER MAINTENANCE
HORIZON AG & TURF CALGARY
HORIZON AG & TURF WEST EDMONTON
OAKCREEK GOLF & TURF
BUSINESS SOFTWARE BUILTRIGHT
CHEMICALS
BELCHIM TURF PROTECTION CANADA
NUTRIEN SOLUTIONS | EVERGRO DIVISION
CONSULTING
SKY LINE NET INSTALLATIONS INC.
WOOD BAY TURF TECHNOLOGIES
EARTHMOVING EQUIPMENT
MECALAC NORTH AMERICA
ENGINES
OAKCREEK GOLF & TURF
EQUIPMENT PARTS
DR MOWER PARTS FIBRAMULCH
EQUIPMENT RENTALS FIBRAMULCH
EROSION CONTROL FIBRAMULCH
FENCING
FIBRAMULCH
REDDEN NET CUSTOM NETS LTD.
SKY LINE NET INSTALLATIONS INC.
FERTILIZER
FIBRAMULCH
MARMIC SOLUTIONS
MINROCK TECHNOLOGIES INC.
NUTRIEN SOLUTIONS | EVERGRO DIVISION
GOLF COURSE ACCESSORIES
GREENJACKET SPORT TURF COVERS
HORIZON AG & TURF CALGARY
HORIZON AG & TURF WEST EDMONTON
REDDEN NET CUSTOM NETS LTD. WALLAH SIGNS
GROOMERS, GOLF
HORIZON AG & TURF CALGARY
HORIZON AG & TURF WEST EDMONTON
OAKCREEK GOLF & TURF
GROOMERS, SPORT TURF
FIBRAMULCH
HORIZON AG & TURF CALGARY
HORIZON AG & TURF WEST EDMONTON
OAKCREEK GOLF & TURF
GROWTH ENHANCERS
BELCHIM TURF PROTECTION CANADA
FIBRAMULCH
MARMIC SOLUTIONS
HYDROSEEDING FIBRAMULCH
INSECT/MOSQUITO CONTROL
PILGRIM PEST PROFESSIONALS
IRRIGATION
CARLYLE AND COMPANY
OAKCREEK GOLF & TURF
RAIN BIRD CORPORATION
LAKE/POND MANAGEMENT
MINROCK TECHNOLOGIES INC.
OAKCREEK GOLF & TURF
LANDSCAPING EQUIPMENT, HANDHELD (BATTERY)
GREENWORKS TOOLS CANADA
HORIZON AG & TURF CALGARY
HORIZON AG & TURF WEST EDMONTON
TROJAN BATTERY COMPANY
LANDSCAPING EQUIPMENT, HANDHELD (GAS)
FIBRAMULCH
HORIZON AG & TURF CALGARY
HORIZON AG & TURF WEST EDMONTON
LANDSCAPING SUPPLIES/MATERIALS
ACTION SUPPLIES INC.
FIBRAMULCH
TROJAN BATTERY COMPANY
LIGHTING
MAKITA CANADA INC.
MOWERS (BATTERY-POWERED)
GREENWORKS TOOLS CANADA
MOWERS, GOLF
CUB CADET
GREENWORKS TOOLS CANADA
HORIZON AG & TURF CALGARY
HORIZON AG & TURF WEST EDMONTON
MAKITA CANADA INC.
OAKCREEK GOLF & TURF
MOWERS, LANDSCAPING
CUB CADET
GREENWORKS TOOLS CANADA
HORIZON AG & TURF CALGARY
HORIZON AG & TURF WEST EDMONTON
MCL CONTRACTING - LANDSCAPING
CHRISTCHURCH
OAKCREEK GOLF & TURF
MULCH
FIBRAMULCH
NETTING/FENCING
FIBRAMULCH
REDDEN NET CUSTOM NETS LTD.
SKY LINE NET INSTALLATIONS INC.
PIPING, GOLF COURSE
OAKCREEK GOLF & TURF
PUMPS/PUMPING STATIONS
OAKCREEK GOLF & TURF
RAIN BIRD CORPORATION
REEL GRINDING EQUIPMENT
HORIZON AG & TURF CALGARY
HORIZON AG & TURF WEST EDMONTON
OAKCREEK GOLF & TURF
SEED
FIBRAMULCH
NUTRIEN SOLUTIONS | EVERGRO DIVISION
SEEDERS
FIBRAMULCH
OAKCREEK GOLF & TURF
SIGNAGE
CANADIAN ROCK SIGNS LTD.
WALLAH SIGNS
SNOW REMOVAL EQUIPMENT/ BLOWERS
FIBRAMULCH
GREENWORKS TOOLS CANADA
SNOW/ICE REMOVAL, SALT/DE-ICERS
CANADASALT GROUP LTD
CUB CADET
HORIZON AG & TURF CALGARY
HORIZON AG & TURF WEST EDMONTON
MECALAC NORTH AMERICA
OAKCREEK GOLF & TURF
SOIL CONDITIONERS/AMENDMENTS/ MIXTURES
BELCHIM TURF PROTECTION CANADA
FIBRAMULCH
MARMIC SOLUTIONS
MINROCK TECHNOLOGIES INC.
SOIL PREPARATION
FIBRAMULCH
SPRAYERS
FIBRAMULCH
HORIZON AG & TURF CALGARY
HORIZON AG & TURF WEST EDMONTON
SPREADERS
CUB CADET
HORIZON AG & TURF CALGARY
HORIZON AG & TURF WEST EDMONTON
OAKCREEK GOLF & TURF
SYNTHETIC TURF SUPPLIES/ EQUIPMENT
OAKCREEK GOLF & TURF
WOOD BAY TURF TECHNOLOGIES
TOPDRESSING MATERIALS/ EQUIPMENT
FIBRAMULCH
HORIZON AG & TURF CALGARY
HORIZON AG & TURF WEST EDMONTON
OAKCREEK GOLF & TURF
WOOD BAY TURF TECHNOLOGIES
TRAILERS
TALBERT MANUFACTURING
TREE CARE EQUIPMENT
MAKITA CANADA INC.
TURF CARE ACCESSORIES
BELCHIM TURF PROTECTION CANADA
FIBRAMULCH
GREENJACKET SPORT TURF COVERS
HORIZON AG & TURF CALGARY
HORIZON AG & TURF WEST EDMONTON
TROJAN BATTERY COMPANY
WOOD BAY TURF TECHNOLOGIES








TURF COVERS
ARCTIC TURF SHIELD
GREENJACKET SPORT TURF COVERS
TURF POWER EQUIPMENT
BUFFALO TURBINE
CUB CADET FIBRAMULCH
HORIZON AG & TURF CALGARY
HORIZON AG & TURF WEST
EDMONTON
MAKITA CANADA INC.
MECALAC NORTH AMERICA
OAKCREEK GOLF & TURF
TROJAN BATTERY COMPANY
WOOD BAY TURF
TECHNOLOGIES
TURF TIRES
CUB CADET
OAKCREEK GOLF & TURF
CUUMS
HORIZON AG & TURF
CALGARY
HORIZON AG & TURF WEST
EDMONTON
MAKITA CANADA INC.
OAKCREEK GOLF & TURF
WEATHER MONITORING
HORIZON AG & TURF
CALGARY
HORIZON AG & TURF WEST
EDMONTON
OAKCREEK GOLF & TURF
WETTING AGENTS
FIBRAMULCH
MARMIC SOLUTIONS
ACTION SUPPLIES INC.
51 Observatory Ln
Richmond Hill ON L4C 8K9
Tel: 647-227-1357
e-mail: info@actionsupplies.ca Website: actionsupplies.ca
BELCHIM TURF
PROTECTION CANADA
104 Cooper Dr., Unit 3 Guelph ON N1C 0A4
Tel: 519-826-7878
Toll free: 866-613-3336
Fax: 519-826-7675
e-mail: barry.johnson@ belchim.com Website: belchimturf.ca
BUFFALO TURBINE
180 Zoar Valley Road Springville NY 14141
Tel: 716-592-2700
e-mail: btsales@ buffaloturbine.com Website: buffaloturbine.com
BUILTRIGHT
131 Continental Drive Newark DE 19713
Tel: 470-264-9485
e-mail: team@builtright.com Website: builtright.co
CANADASALT GROUP LTD
10638 9th Line, Markham, ON Markham BC L6B 1A8
Tel: 866-321-7258
e-mail: sales@canadasalt.ca Website: canadasalt.ca
CUB CADET
Tel: 800-668-1238
Toll free: 800-668-1238
Fax: 800-668-6677
e-mail: kevindunbar@ cubcadet.com Website: cubcadet.ca
DR MOWER PARTS
5-1304-44 Ave NE
Calgary AB T2E 6L6
Tel: 587-329-6642
Toll free: 877-531-2873
e-mail: parts@drmower.ca Website: drmower.ca

FIBRAMULCH
29 Killaloe Rd, Unit 2 CONCORD ON L4K 2A8
Tel: 905-761-6969
Website: fibramulch.com
Description: For almost 50 years, FIBRAMULCH has delivered knowledgeable advice, service, rentals and products for Erosion Control, Sediment Control & Land Reclamation. Proud partners of DLF, LSC, Profile, FINN, ABI & TurfTeq. We’re your onestop-shop—call us today!
GREENWORKS TOOLS
CANADA
67 Toll Rd
Holland Landing ON L9N 1H2
Tel: 416-859-9878
e-mail: gwcanadaprograms@ greenworkstools.com
MAKITA CANADA INC.
1950 Forbes Street
Whitby ON L1N 7B7
Tel: 905-809-0152
Toll free: 800-263-3734
e-mail: s.ottewell@makita.ca
Website: makita.ca
MARMIC SOLUTIONS
795 Rathbourne Ave
Woodstock ON N4S 4L8
Tel: 519-421-6783
e-mail: mkean@mjkean.com Website: marmicsolutions.com
MECALAC NORTH AMERICA
282 Dedham Street
Norfolk MA 02056
Tel: 508-921-3076
e-mail: mecalac.northamerica@mecalac. com Website: mecalac.com/en
MINROCK TECHNOLOGIES INC.
PO. Box 1522, Woodstock Station Main
Woodstock ON N4S 0A7
Tel: 519-421-6783
e-mail: mkean@mjkean.com Website: minrocktechnologies.com
OAKCREEK GOLF & TURF
111 Eldorado Street
Warman SK S7N 1Y3
Tel: 306-975-1110
Toll free: 888-773-7335
Fax: 306-975-1184
e-mail: mccormickb@oakcreekgolf.com Website: oakcreekgolf.com
PILGRIM PEST PROFESSIONALS
26 Palmer Rd
Plymouth MA 02360
Tel: 508-208-3864
e-mail: marketing@pilgrimpestpro.com Website: pilgrimpestpro.com/pest-control
RAIN BIRD CORPORATION
6991 East Southpoint Road
Tucson AZ 85756
Tel: 587-575-5775
e-mail: dzabel@rainbird.com Website: rainbird.com
REDDEN NET CUSTOM NETS LTD.
5620 198th St.
Langley BC V3A 7C7
Tel: 604-530-2213
Toll free: 800-667-9455
Fax: 604-530-2218
e-mail: info@redden-net.com Website: redden-net.com
SKY LINE NET INSTALLATIONS INC.
21458 24th Ave.
Langley BC V2Z 2A8
Tel: 604-328-1474
e-mail: greg@skynets.ca Website: skynets.ca
TALBERT MANUFACTURING
1628 W. State Road 114
Rensselaer IN 47978
Tel: 800-348-5232
e-mail: sales@talbertmfg.com Website: talbertmfg.com
TROJAN BATTERY COMPANY
12380 Clark Street
Santa Fe Springs CA 90670
Tel: 800-423-6569
e-mail: technical@trojanbattery.com Website: trojanbattery.com
AERATION/OVERSEEDING SERVICE
FIBRAMULCH
OAKCREEK GOLF & TURF
AERATORS - SOIL FIBRAMULCH
OAKCREEK GOLF & TURF
AERATORS - WATER
OAKCREEK GOLF & TURF
ARCHITECTS, SPORTS FIELDS REDDEN NET CUSTOM NETS LTD. SKY LINE NET INSTALLATIONS INC.
ARCHITECTS/CONTRACTORS, GOLF COURSE REDDEN NET CUSTOM NETS LTD. SKY LINE NET INSTALLATIONS INC.
BALL DIAMOND GREEN FIBRAMULCH
BLOWER TRUCK OR MATERIAL BLOWER FIBRAMULCH
BUNKER MAINTENANCE
OAKCREEK GOLF & TURF
BUSINESS SOFTWARE BUILTRIGHT
CHEMICALS
BELCHIM TURF PROTECTION CANADA
CONSULTING
SKY LINE NET INSTALLATIONS INC.
EARTHMOVING EQUIPMENT MECALAC NORTH AMERICA
ENGINES
OAKCREEK GOLF & TURF
EQUIPMENT PARTS
DR MOWER PARTS
FIBRAMULCH
EQUIPMENT RENTALS
FIBRAMULCH
EROSION CONTROL
FIBRAMULCH
FENCING
FIBRAMULCH
REDDEN NET CUSTOM NETS LTD.
SKY LINE NET INSTALLATIONS INC.
FERTILIZER
FIBRAMULCH
MARMIC SOLUTIONS
MINROCK TECHNOLOGIES INC.
GOLF COURSE ACCESSORIES
REDDEN NET CUSTOM NETS LTD.
GROOMERS, GOLF
OAKCREEK GOLF & TURF
GROOMERS, SPORT TURF
FIBRAMULCH
OAKCREEK GOLF & TURF
GROWTH ENHANCERS
BELCHIM TURF PROTECTION CANADA
FIBRAMULCH
MARMIC SOLUTIONS
HYDROSEEDING
FIBRAMULCH
INSECT/MOSQUITO CONTROL
PILGRIM PEST PROFESSIONALS
IRRIGATION
OAKCREEK GOLF & TURF
RAIN BIRD CORPORATION
LAKE/POND MANAGEMENT
MINROCK TECHNOLOGIES INC.
OAKCREEK GOLF & TURF
LANDSCAPING EQUIPMENT, HANDHELD (BATTERY)
GREENWORKS TOOLS CANADA
TROJAN BATTERY COMPANY
LANDSCAPING EQUIPMENT, HANDHELD (GAS)
FIBRAMULCH
LANDSCAPING SUPPLIES/MATERIALS
ACTION SUPPLIES INC.
FIBRAMULCH
TROJAN BATTERY COMPANY
LIGHTING
MAKITA CANADA INC.
MOWERS (BATTERY-POWERED)
GREENWORKS TOOLS CANADA
MOWERS, GOLF
CUB CADET
GREENWORKS TOOLS CANADA
MAKITA CANADA INC.
OAKCREEK GOLF & TURF
MOWERS, LANDSCAPING
CUB CADET
GREENWORKS TOOLS CANADA
OAKCREEK GOLF & TURF
MULCH
FIBRAMULCH
NETTING/FENCING FIBRAMULCH
REDDEN NET CUSTOM NETS LTD.
SKY LINE NET INSTALLATIONS INC.
PIPING, GOLF COURSE
OAKCREEK GOLF & TURF
PUMPS/PUMPING STATIONS
OAKCREEK GOLF & TURF
RAIN BIRD CORPORATION
REEL GRINDING EQUIPMENT
OAKCREEK GOLF & TURF
SEED
FIBRAMULCH
SEEDERS
FIBRAMULCH
OAKCREEK GOLF & TURF
SNOW REMOVAL EQUIPMENT/ BLOWERS
FIBRAMULCH
GREENWORKS TOOLS CANADA
SNOW/ICE REMOVAL, SALT/DE-ICERS
CANADASALT GROUP LTD
CUB CADET
MECALAC NORTH AMERICA
OAKCREEK GOLF & TURF
SOIL CONDITIONERS/AMENDMENTS/ MIXTURES
BELCHIM TURF PROTECTION CANADA
FIBRAMULCH
MARMIC SOLUTIONS
MINROCK TECHNOLOGIES INC.
OAKCREEK GOLF & TURF
SOIL PREPARATION
FIBRAMULCH
ACTION SUPPLIES INC.
51 Observatory Ln
Richmond Hill ON L4C 8K9
Tel: 647-227-1357
e-mail: info@actionsupplies.ca
Website: actionsupplies.ca
BELCHIM TURF PROTECTION
CANADA
104 Cooper Dr., Unit 3
Guelph ON N1C 0A4
Tel: 519-826-7878
Toll free: 866-613-3336
Fax: 519-826-7675
e-mail: barry.johnson@belchim.com Website: belchimturf.ca
BUFFALO TURBINE
180 Zoar Valley Road
Springville NY 14141
Tel: 716-592-2700
e-mail: btsales@buffaloturbine.com
Website: buffaloturbine.com
BUILTRIGHT
131 Continental Drive
Newark DE 19713
Tel: 470-264-9485
e-mail: team@builtright.com
Website: builtright.co
CANADASALT GROUP LTD
10638 9th Line, Markham, ON Markham BC L6B 1A8
Tel: 866-321-7258
e-mail: sales@canadasalt.ca Website: canadasalt.ca
CANITAL GRANITE LTD.
100 Hoka St., Unit 100 Winnipeg MB R2C 3N2
Tel: 204-224-2286
e-mail: info@canitalgranite.com Website: canitalgranite.com
SPRAYERS
FIBRAMULCH
SPREADERS
CUB CADET
OAKCREEK GOLF & TURF
SYNTHETIC TURF SUPPLIES/ EQUIPMENT
OAKCREEK GOLF & TURF
TOPDRESSING MATERIALS/ EQUIPMENT
FIBRAMULCH
OAKCREEK GOLF & TURF
TRAILERS
TALBERT MANUFACTURING
TREE CARE EQUIPMENT
MAKITA CANADA INC.
TURF CARE ACCESSORIES
BELCHIM TURF PROTECTION CANADA
FIBRAMULCH
TROJAN BATTERY COMPANY
CUB CADET
Tel: 800-668-1238
Toll free: 800-668-1238
Fax: 800-668-6677
e-mail: kevindunbar@cubcadet.com
Website: cubcadet.ca
DR MOWER PARTS
5-1304-44 Ave NE Calgary AB T2E 6L6
Tel: 587-329-6642
Toll free: 877-531-2873
e-mail: parts@drmower.ca
Website: drmower.ca

FIBRAMULCH
29 Killaloe Rd, Unit 2 CONCORD ON L4K 2A8
Tel: 905-761-6969
Website: fibramulch.com
Description: For almost 50 years, FIBRAMULCH has delivered knowledgeable advice, service, rentals and products for Erosion Control, Sediment Control & Land Reclamation. Proud partners of DLF, LSC, Profile, FINN, ABI & TurfTeq. We’re your one-stopshop—call us today!
GREENWORKS TOOLS CANADA
67 Toll Rd
Holland Landing ON L9N 1H2
Tel: 416-859-9878
e-mail: gwcanadaprograms@ greenworkstools.com
TURF POWER EQUIPMENT
BUFFALO TURBINE
CUB CADET
FIBRAMULCH
MAKITA CANADA INC.
MECALAC NORTH AMERICA
OAKCREEK GOLF & TURF
TROJAN BATTERY COMPANY
TURF TIRES
CUB CADET
OAKCREEK GOLF & TURF
VACUUMS
MAKITA CANADA INC.
OAKCREEK GOLF & TURF
WETTING AGENTS
FIBRAMULCH
MARMIC SOLUTIONS
MAKITA CANADA INC.
1950 Forbes Street
Whitby ON L1N 7B7
Tel: 905-809-0152
Toll free: 800-263-3734
e-mail: s.ottewell@makita.ca
Website: makita.ca
MARMIC SOLUTIONS
795 Rathbourne Ave
Woodstock ON N4S 4L8
Tel: 519-421-6783
e-mail: mkean@mjkean.com
Website: marmicsolutions.com
MECALAC NORTH AMERICA
282 Dedham Street Norfolk MA 02056
Tel: 508-921-3076
e-mail: mecalac.northamerica@mecalac. com
Website: mecalac.com/en
MINROCK TECHNOLOGIES INC.
PO. Box 1522, Woodstock Station Main Woodstock ON N4S 0A7
Tel: 519-421-6783
e-mail: mkean@mjkean.com Website: minrocktechnologies.com
PILGRIM PEST PROFESSIONALS 26 Palmer Rd Plymouth MA 02360 Tel: 508-208-3864
e-mail: marketing@pilgrimpestpro.com Website: pilgrimpestpro.com/pest-control
RAIN BIRD CORPORATION
6991 East Southpoint Road Tucson AZ 85756
Tel: 587-575-5775
e-mail: dzabel@rainbird.com Website: rainbird.com
REDDEN NET CUSTOM NETS LTD.
5620 198th St.
Langley BC V3A 7C7
Tel: 604-530-2213
Toll free: 800-667-9455
Fax: 604-530-2218
e-mail: info@redden-net.com Website: redden-net.com
SKY LINE NET INSTALLATIONS INC.
21458 24th Ave.
Langley BC V2Z 2A8
Tel: 604-328-1474
e-mail: greg@skynets.ca Website: skynets.ca
TALBERT MANUFACTURING
1628 W. State Road 114
Rensselaer IN 47978
Tel: 800-348-5232
e-mail: sales@talbertmfg.com Website: talbertmfg.com

TEKTITE MANUFACTURING INC.
427 Buffalo St
Winkler MB R6W 4B2
Tel: 204-331-3463
e-mail: sales@tektite.ca
Website: tektite.ca
Description: Tektite manufactures ROPS cabs for small horsepower tractors. We’ve designed options for Deere, Kubota, Massey, Toro, Smithco, Jacobson and more. Our products arrive fully welded and assemble to save you time on installation. Air conditioning available on some models.
TROJAN BATTERY COMPANY
12380 Clark Street
Santa Fe Springs CA 90670
Tel: 800-423-6569
e-mail: technical@trojanbattery.com Website: trojanbattery.com
CATEGORIES:
AERATION/OVERSEEDING SERVICE FIBRAMULCH
AERATORS - SOIL FIBRAMULCH
ARCHITECTS, SPORTS FIELDS REDDEN NET CUSTOM NETS LTD. SKY LINE NET INSTALLATIONS INC.
ARCHITECTS/CONTRACTORS, GOLF COURSE
REDDEN NET CUSTOM NETS LTD. SKY LINE NET INSTALLATIONS INC.
BALL DIAMOND GREEN FIBRAMULCH
BLOWER TRUCK OR MATERIAL BLOWER FIBRAMULCH
BUSINESS SOFTWARE BUILTRIGHT
CHEMICALS
BELCHIM TURF PROTECTION CANADA
CONSULTING SKY LINE NET INSTALLATIONS INC.
EARTHMOVING EQUIPMENT MECALAC NORTH AMERICA
EQUIPMENT PARTS
DR MOWER PARTS FIBRAMULCH
EQUIPMENT RENTALS FIBRAMULCH
EROSION CONTROL FIBRAMULCH
FENCING FIBRAMULCH
REDDEN NET CUSTOM NETS LTD. SKY LINE NET INSTALLATIONS INC.
FERTILIZER FIBRAMULCH
MARMIC SOLUTIONS MINROCK TECHNOLOGIES INC.
GOLF COURSE ACCESSORIES REDDEN NET CUSTOM NETS LTD.
GROOMERS, SPORT TURF FIBRAMULCH
GROWTH ENHANCERS
BELCHIM TURF PROTECTION CANADA FIBRAMULCH MARMIC SOLUTIONS
HYDROSEEDING FIBRAMULCH
INSECT/MOSQUITO CONTROL PILGRIM PEST PROFESSIONALS
IRRIGATION
RAIN BIRD CORPORATION
LAKE/POND MANAGEMENT
MINROCK TECHNOLOGIES INC.
LANDSCAPING EQUIPMENT, HANDHELD (BATTERY)
GREENWORKS TOOLS CANADA
TROJAN BATTERY COMPANY
LANDSCAPING EQUIPMENT, HANDHELD (GAS)
FIBRAMULCH
LANDSCAPING SUPPLIES/MATERIALS
ACTION SUPPLIES INC. FIBRAMULCH
TROJAN BATTERY COMPANY
LIGHTING
MAKITA CANADA INC.
MOWERS (BATTERY-POWERED)
GREENWORKS TOOLS CANADA
MOWERS, GOLF CUB CADET
GREENWORKS TOOLS CANADA
MAKITA CANADA INC.
MOWERS, LANDSCAPING CUB CADET
GREENWORKS TOOLS CANADA
MULCH FIBRAMULCH
NETTING/FENCING
FIBRAMULCH
REDDEN NET CUSTOM NETS LTD.
SKY LINE NET INSTALLATIONS INC.
PUMPS/PUMPING STATIONS
RAIN BIRD CORPORATION
SEED FIBRAMULCH
SEEDERS FIBRAMULCH
SIGNAGE CANITAL GRANITE LTD.
SNOW REMOVAL EQUIPMENT/ BLOWERS FIBRAMULCH
GREENWORKS TOOLS CANADA
SNOW/ICE REMOVAL, SALT/DE-ICERS
CANADASALT GROUP LTD CUB CADET
MECALAC NORTH AMERICA
SOIL CONDITIONERS/AMENDMENTS/ MIXTURES
BELCHIM TURF PROTECTION CANADA FIBRAMULCH
MARMIC SOLUTIONS
MINROCK TECHNOLOGIES INC.
SOIL PREPARATION FIBRAMULCH
SPRAYERS FIBRAMULCH
SPREADERS
CUB CADET
TOPDRESSING MATERIALS/ EQUIPMENT FIBRAMULCH
TRAILERS
TALBERT MANUFACTURING
TREE CARE EQUIPMENT
MAKITA CANADA INC.
TURF CARE ACCESSORIES
BELCHIM TURF PROTECTION CANADA FIBRAMULCH
TROJAN BATTERY COMPANY
TURF POWER EQUIPMENT
BUFFALO TURBINE CUB CADET
FIBRAMULCH
MAKITA CANADA INC. MECALAC NORTH AMERICA
ACTION SUPPLIES INC.
51 Observatory Ln
Richmond Hill ON L4C 8K9
Tel: 647-227-1357
e-mail: info@actionsupplies.ca
Website: actionsupplies.ca
ANDERSONS, THE
PO Box 119, 1947 Briarfield Blvd
Maumee OH 43537
Tel: 419-891-2779
Toll free: 800-253-5296
e-mail: lawncs@andersonsinc.com
Website: andersonspro.com
BAG-A-SIGN
213 Ashland Ave.
London ON N5W 4E3
Tel: 800-668-7017
e-mail: bagasign213@gmail.com
Website: bagasign.ca
Description: Pesticide Signs as per Government Regulations
Plastic Signs with Steel Frames For Residential, Commercial, and Industrial Uses
BANNERMAN LTD.
41 Kelfield St.
Rexdale ON M9W 5A3
Tel: 800-325-4871
Toll free: 800-325-4871
Fax: 416-247-6540
e-mail: info@sportsturfmagic.com Website: sportsturfmagic.com
BAUMAN MANUFACTURING
3 Industrial Drive
Elmira ON N4B 2S1
Tel: 519-669-4333
e-mail: sales@baumanmfg.com Website: baumanmfg.com
BELCHIM TURF PROTECTION CANADA
104 Cooper Dr., Unit 3
Guelph ON N1C 0A4
Tel: 519-826-7878
Toll free: 866-613-3336
Fax: 519-826-7675
e-mail: barry.johnson@belchim.com Website: belchimturf.ca
TEKTITE MANUFACTURING INC. TROJAN BATTERY COMPANY
TURF TIRES CUB CADET

BROCK AGGREGATES INC.
401 Bowes Road
Concord ON L4K 1J4
Tel: 416-798-7050
Toll free: 800-870-0926
e-mail: orders@brockaggregates.com
Website: Brockaggregates.com
Description: Brock Aggregates is widely recognized and trusted for our highquality aggregates and superior customer service. We are one of the leading suppliers in Southern Ontario for quality sand, stone, gravel, 3/4 crush, crusher run limestone, and limestone screenings. Brock Aggregates continues to grow to supply the industry with the highest quality aggregates available. A Juel Group Company
BROUWER KESMAC
23324 Woodbine Ave.
Keswick ON L4P 0N1
Tel: 905-476-6222
Toll free: 888-341-5113
Fax: 905-476-6744
e-mail: info@kesmac.com
Website: brouwerkesmac.com
BUFFALO TURBINE
180 Zoar Valley Road
Springville NY 14141
Tel: 716-592-2700
e-mail: btsales@buffaloturbine.com Website: buffaloturbine.com
BUILTRIGHT
131 Continental Drive
Newark DE 19713
Tel: 470-264-9485
e-mail: team@builtright.com
Website: builtright.co
CANADASALT GROUP LTD
10638 9th Line, Markham, ON Markham BC L6B 1A8
Tel: 866-321-7258
e-mail: sales@canadasalt.ca
Website: canadasalt.ca
VACUUMS MAKITA CANADA INC.
WETTING AGENTS FIBRAMULCH MARMIC SOLUTIONS

CLEAN TURF CANADA INC.
380 Vansickle Rd, Unit 460
St. Catherines ON L2S 0B5
Tel: 289-479-1036
e-mail: info@cleanturfcanada.com
Website: cleanturfcanada.com
Description: Clean Turf Canada has the most advanced equipment for maintenance of artificial turf fields. We offer services and maintenance programs for schools, municipalities, athletic facilities etc.
CUB CADET
97 Kent Ave.
Kitchener ON N2G 3R2
Tel: 800-668-1238
Toll free: 800-668-1238
Fax: 800-668-6677
e-mail: kevindunbar@cubcadet.com
Website: cubcadet.ca
DIRT CHEAP INC. - KITCHENER
43 Manitou Drive, Kitchener, ON N2C 1K9, 43 Manitou Drive
Kitchener, ON, Canada ON N2C1K9
Tel: 519-804-4300
Website: dirtcheap.ca
DLF PICKSEED CANADA INC.
1 Greenfield Rd.
Lindsay ON K9V 4S3
Tel: 705-878-9240
e-mail: info@dlfpickseed.com Website: dlfpickseed.ca

DRAGLAM SALT
401 Bowes Road
Concord ON L4K 1J4
Tel: 416-798-7050
Toll free: 888-907-7258
Fax: 905-738-5228
e-mail: deice@draglamsalt.com
Website: draglamsalt.com
Description: Draglam Salt has been a leader in the bulk road salt and deicing industry for over 30 years. Today, Draglam Salt has proudly grown to have multiple convenient locations servicing the entire GTA and all of Southern Ontario. We also proudly provide environmentally friendly alternatives in addition to more traditional forms of snow and ice melting products. A Juel Group Company
DR MOWER PARTS
5-1304-44 Ave NE
Calgary AB T2E 6L6
Tel: 587-329-6642
Toll free: 877-531-2873
e-mail: parts@drmower.ca
Website: drmower.ca

EARTHCO SOIL MIXTURES
401 Bowes Road
Concord ON L4K 1J4
Tel: 416-798-7050
e-mail: orders@earthcosoils.com
Website: earthcosoils.com
Description: Earthco Soil Mixtures is a leader in the Landscape and Horticulture industries and contributes to our client’s success by understanding and appreciating their soil requirements. Whether they need regular topsoil or custom soil blends, we utilize innovative, custom solutions to provide fertile soil products and viable services to our industry and community. A Juel Group Company
EASTERN FARM MACHINERY LTD.
10 Nicholas Beaver Rd.
Puslinch ON N0B 2J0
Tel: 519-763-2400
Fax: 519-763-3930
e-mail: sales@easternfarmmachinery.com Website: easternfarmmachinery.com


ECHO POWER EQUIPMENT (CANADA)
311 Sovereign Road
London ON N6M 1A6
Tel: 519-685-7011
Toll free: 877-324-6665
Fax: 877-324-6668
e-mail: info@echo.ca
Website: echo.ca
Description: Dedicated exclusively to outdoor power for 50+ years, ECHO is a leader in the development and manufacturing of commercial-grade outdoor power equipment, providing gas- and battery-powered tools with the highest level of performance, quality, and reliability for both professional landscapers and homeowners alike. Backed by an industry leading 5 year consumer warranty and 2 year commercial warranty.
ECOLAWN AERATOR INC.
21 Villa Crt
Chatham ON N7L 5P5
Tel: 226-314-1745
e-mail: ecolawnaerator@gmail.com
Website: ecolawnaerator.ca
EVERGREEN TURF COVERS
645 Needham Lane
Mississauga ON L5A 1T9
Tel: 905-272-0144
Toll free: 800-461-3215
Fax: 905-272-3769
e-mail: sales@hinspergers.com
Website: evergreenturfcovers.com

29 Killaloe Rd, Unit 2
CONCORD ON L4K 2A8
Tel: 905-761-6969
Website: fibramulch.com
Description: For almost 50 years, FIBRAMULCH has delivered knowledgeable advice, service, rentals and products for Erosion Control, Sediment Control & Land Reclamation. Proud partners of DLF, LSC, Profile, FINN, ABI & TurfTeq. We’re your one-stopshop—call us today!
FISH FARM SUPPLY CO. INC.
116 Bonnie Crescent
Elmira ON N3B 3J8
Tel: 519-669-1096
Toll free: 877-669-1096
e-mail: info@fishfarmsupply.ca
Website: FishFarmSupply.ca
Description: Fish Farm Supply Co. has been helping customers find the right products to take care of their Lakes and Ponds since 1989. We have always worked hard to source the best possible products from all over the world to simplify our customer’s lives and make their jobs easier. We look forward to the opportunity to help you maintain your ponds with simply and affordable products.
G.C. DUKE EQUIPMENT LTD.
1184 Plains Rd. E.
Burlington ON L7S 1W6
Tel: 905-637-5216
Toll free: 800-883-0761
Fax: 905-637-2009
e-mail: nduke@gcduke.com
Website: gcduke.com
GENERAL EQUIPMENT COMPANY
620 Alexander Dr. SW Owatonna MN 55060
Tel: 800-533-0524
Toll free: 800-533-0524
Fax: 877-344-4375
e-mail: sales@generalequip.com
Website: generalequip.com
GENERAL SEED COMPANY
648 Alberton Rd.
Alberton ON L0R 1A0
Tel: 905-975-8986
e-mail: generalseedcompany@gmail.com
Website: generalseedcompany.ca
GEORGE DE GROOT LASER GRADING & EXCAVATING INC.
PO Box 1129
Virgil ON L0S 1T0
Tel: 905-933-7810
e-mail: info@degrootlasergrading.com
Website: degrootlasergrading.com
Description: We expertise in precision laser grading for all kinds of sports projects. With our advanced equipment we can make your base perfectly flat or slope, whatever is required.
GREENWORKS TOOLS CANADA
67 Toll Rd
Holland Landing ON L9N 1H2
Tel: 416-859-9878
e-mail: gwcanadaprograms@ greenworkstools.com
HLA SNOW
8082 Road 129
Listowel ON N4W3G8
Tel: 519-291-4162
e-mail: sales@horstwelding.com
Website: hlasnow.com
HYBRIDTURF.COM
15B Bentley Ave.
Ottawa ON K2E 6T7
Tel: 613-601-1384
e-mail: info@hybridturf.com
Website: hybridsturf.com
LAKE SHORE SAND
800 Strathearne Ave. North, PO Box 47573, Centre Mall, Hamilton ON L8H 7S7
Tel: 905-516-0136
e-mail: eric.porter@coviacorp.com
Website: coviacorp.com

LESS MESS ENVIRO BAG
401 Bowes Road
Concord ON L4K 1J4
Tel: 416-789-4749
Toll free: 833-955-9595
e-mail: orderdesk@lessmess.ca
Website: LessMess.ca
Description: Less Mess is delivered in pre-packaged, resealable bags that let you keep materials dry and store more aggregate and soil in less space. Easily lift for rooftop applications and cut down on labour costs so you can save money. Less Mess is ideal for sites with less space and no room for standard truckloads. Keep materials dry and uncontaminated and even reuse for waste disposal.
MAKITA CANADA INC.
1950 Forbes Street
Whitby ON L1N 7B7
Tel: 905-809-0152
Toll free: 800-263-3734
e-mail: s.ottewell@makita.ca
Website: makita.ca
MARMIC SOLUTIONS
795 Rathbourne Ave
Woodstock ON N4S 4L8
Tel: 519-421-6783
e-mail: mkean@mjkean.com
Website: marmicsolutions.com
MECALAC NORTH AMERICA
282 Dedham Street
Norfolk MA 02056
Tel: 508-921-3076
e-mail: mecalac.northamerica@mecalac. com
Website: mecalac.com/en
MINROCK TECHNOLOGIES INC.
PO. Box 1522, Woodstock Station Main Woodstock ON N4S 0A7
Tel: 519-421-6783
e-mail: mkean@mjkean.com
Website: minrocktechnologies.com
NUTRITE
5063 North Service Rd, Suite 200 Burlington ON L7L 5H6
Tel: 519-249-0600
Toll free: 800-265-8865
e-mail: customer.service@nutrite.com
Website: nutrite.com
NUTRITE, A DIVISION OF FERTITECHNOLOGIES INC.
560 Chemin Rheaume
St. Michel QC J0L 2J0
Tel: 450-454-5367
Toll free: 800-265-8865
e-mail: kmcleod@fertitechno.com
Website: nutrite.com
PILGRIM PEST PROFESSIONALS
26 Palmer Rd Plymouth MA 02360
Tel: 508-208-3864
e-mail: marketing@pilgrimpestpro.com Website: pilgrimpestpro.com/pest-control
PLANT PRODUCTS
1520 Sandhill Drive
Ancaster ON L9C 4V5
Tel: 800-387-2449
Toll free: 800-387-2449
e-mail: info@plantproducts.com
Website: plantproducts.com
Description: Full line distributor of pest control, fertilizer and other consumable goods. Trusted partner in the industry for over 75 years.
PROFESSIONAL LAWN CARE ASSOCIATION OF ONTARIO
537 Frederick Street, PO Bix 23015
Kitchener ON N2B 3V1
Tel: 519-836-4906
Toll free: 877-307-5226
e-mail: placo@gti.uoguelph.ca Website: plcao.on.ca
QUALITY SEEDS LTD.
8400 Huntington Road
Woodbridge ON L4H 4Z6
Tel: 905-856-7333
Toll free: 877-856-7333
e-mail: support@qualityseeds.ca Website: qualityseeds.ca
RAIN BIRD CORPORATION
6991 East Southpoint Road Tucson AZ 85756
Tel: 587-575-5775
e-mail: dzabel@rainbird.com Website: rainbird.com
REDDEN NET CUSTOM NETS LTD.
5620 198th St.
Langley BC V3A 7C7
Tel: 604-530-2213
Toll free: 800-667-9455
Fax: 604-530-2218
e-mail: info@redden-net.com Website: redden-net.com
SKY LINE NET INSTALLATIONS INC.
21458 24th Ave.
Langley BC V2Z 2A8
Tel: 604-328-1474
e-mail: greg@skynets.ca Website: skynets.ca
SOUTHEND EQUIPT TRAILERS
670 Kraft Road
Fort Erie ON L2A 4K2
Tel: 905-658-0188
e-mail: george@southendequipttrailers. come Website: southendequipttrailers.com
STIHL LIMITED
1515 Sise Road, PO Box 5666 London ON N6A 4L6
Tel: 519-681-3000
e-mail: info.canada@stihl.ca Website: stihl.ca
TALBERT MANUFACTURING
1628 W. State Road 114 Rensselaer IN 47978
Tel: 800-348-5232
e-mail: sales@talbertmfg.com Website: talbertmfg.com
TARGET SPECIALTY PRODUCTS
3325 N. Service Road, Units 104 & 105 Burlington ON L7N 3G2
Tel: 800-760-1835
e-mail: info@target-specialty.com Website: target-specialty.com
THE TORO COMPANY RES/COM IRRIGATION
3 Harriett St
Brantford ON N3S1J1
Tel: 519-755-1755
e-mail: kevin.jensen@toro.com Website: toro.com
TROJAN BATTERY COMPANY
12380 Clark Street
Santa Fe Springs CA 90670
Tel: 800-423-6569
e-mail: technical@trojanbattery.com Website: trojanbattery.com

TURF CARE PRODUCTS CANADA
14 Given Rd., PO Box 159
St. Marys ON N4X 1B1
Tel: 519-349-2300
e-mail: canadiancartsales@turfcare.ca
Website: turfcare.ca/en/canadian-cart-sales
Description: Canadian Cart Sales, a division of Turf Care Products Canada, is the Exclusive Yamaha Golf Car Dealer for Eastern Canada. Whether you need a leasing program for your golf course or a personal car for your cottage or trailer, Canadian Cart Sales and Turf Care have you covered with a wide selection of new Yamaha vehicles as well as a large inventory of pre-owned cars.


TURF CARE PRODUCTS CANADA
200 Pony Dr.
Newmarket ON L3Y 7B6
Tel: 905-836-0988
Toll free: 1-800-561-(TURF) 8873
e-mail: inquiries@turfcare.ca
Website: turfcare.ca
Description: Turf Care is the exclusive Toro Distributor for Eastern Canada as well as representing a wide range of other industry-leading brands including Ventrac, Kawasaki, and Yamaha. Proudly supplying superior quality turf equipment, irrigation systems, pumps, golf cars, parts, and accessories to golf courses, municipalities, corporations, contractors and dealers across Eastern Canada for nearly 50 years.

TURF CARE PRODUCTS CANADA
240 Terence Matthews Cres, Unit 110 Kanata ON K2M 2C4
Tel: 613-839-7474
Toll free: 1-800-561-(TURF) 8873
e-mail: inquiries@turfcare.ca
Website: turfcare.ca
Description: Turf Care is the exclusive Toro Distributor for Eastern Canada as well as representing a wide range of other industry-leading brands including Ventrac, Kawasaki, and Yamaha. Proudly supplying superior quality turf equipment, irrigation systems, pumps, golf cars, parts, and accessories to golf courses, municipalities, corporations, contractors and dealers across Eastern Canada for nearly 50 years.
TURF TALENTS INC.
15B Bentley Ave. Ottawa ON K2E 6T7
Tel: 613-601-1384
e-mail: info@turftalents.com Website: turftalents.com
VANDEN BUSSCHE IRRIGATION
2515 Pinegrove Rd
Delhi ON N4B 2E5
Tel: 800-387-7246
Toll free: 800-387-7246
Fax: 519-582-1514
e-mail: info@vandenbussche.com
Website: vandenbussche.com
Description: With Vanden Bussche Irrigation, you’re not just buying irrigation products - you’re investing in a partnership built on reliability, innovation and exceptional customer support. Our customers benefit from expert sales support shaped by our strong industry expertise & a deep understanding of customer needs built on the trusted values of a family business.
AERATION/OVERSEEDING SERVICE
CLEAN TURF CANADA INC.
FIBRAMULCH
AERATORS - SOIL
BANNERMAN LTD.
BROUWER KESMAC
DIRT CHEAP INC. - KITCHENER
EASTERN FARM MACHINERY LTD.
ECHO POWER EQUIPMENT (CANADA)
ECOLAWN AERATOR INC.
FIBRAMULCH
G.C. DUKE EQUIPMENT LTD.
STIHL LIMITED
TURF CARE PRODUCTS CANADA
AERATORS - WATER
FISH FARM SUPPLY CO. INC.
TURF CARE PRODUCTS CANADA
VANDEN BUSSCHE IRRIGATION
AGGREGATES
BROCK AGGREGATES INC.
DIRT CHEAP INC. - KITCHENER
DRAGLAM SALT
LESS MESS ENVIRO BAG
ARCHITECTS, SPORTS FIELDS
GEORGE DE GROOT LASER GRADING & EXCAVATING INC.
HYBRIDTURF.COM
REDDEN NET CUSTOM NETS LTD.
SKY LINE NET INSTALLATIONS INC.
TURF TALENTS INC.
ARCHITECTS/CONTRACTORS, GOLF COURSE
REDDEN NET CUSTOM NETS LTD.
SKY LINE NET INSTALLATIONS INC.
AUTONOMOUS EQUIPMENT
G.C. DUKE EQUIPMENT LTD.
TURF CARE PRODUCTS CANADA
BALL DIAMOND GREEN FIBRAMULCH
BLOWER TRUCK OR MATERIAL
BLOWER FIBRAMULCH
BUNKER MAINTENANCE
PLANT PRODUCTS
TURF CARE PRODUCTS CANADA
BUSINESS SOFTWARE BUILTRIGHT
CHEMICALS
ANDERSONS, THE
BELCHIM TURF PROTECTION CANADA PLANT PRODUCTS
CONSULTING
CLEAN TURF CANADA INC.
HYBRIDTURF.COM
SKY LINE NET INSTALLATIONS INC.
TURF TALENTS INC.
DRAINAGE
GEORGE DE GROOT LASER GRADING & EXCAVATING INC.
HYBRIDTURF.COM
TURF CARE PRODUCTS CANADA
TURF TALENTS INC.
EARTHMOVING EQUIPMENT
EASTERN FARM MACHINERY LTD.
GEORGE DE GROOT LASER GRADING & EXCAVATING INC.
MECALAC NORTH AMERICA
TURF CARE PRODUCTS CANADA
ENGINES
TURF CARE PRODUCTS CANADA
EQUIPMENT PARTS
DR MOWER PARTS
FIBRAMULCH
G.C. DUKE EQUIPMENT LTD.
TURF CARE PRODUCTS CANADA
EQUIPMENT RENTALS
FIBRAMULCH
SOUTHEND EQUIPT TRAILERS
TURF CARE PRODUCTS CANADA
EROSION CONTROL
FIBRAMULCH
QUALITY SEEDS LTD.
FENCING
FIBRAMULCH
REDDEN NET CUSTOM NETS LTD.
SKY LINE NET INSTALLATIONS INC.
FERTILIZER
ANDERSONS, THE FIBRAMULCH
GENERAL SEED COMPANY
MARMIC SOLUTIONS
MINROCK TECHNOLOGIES INC.
NUTRITE
NUTRITE, A DIVISION OF FERTITECHNOLOGIES INC.
PLANT PRODUCTS
TARGET SPECIALTY PRODUCTS
GOLF COURSE ACCESSORIES
G.C. DUKE EQUIPMENT LTD.
PLANT PRODUCTS
REDDEN NET CUSTOM NETS LTD.
TURF CARE PRODUCTS CANADA
GOOSE/ANIMAL CONTROL
FISH FARM SUPPLY CO. INC.
GPS TECHNOLOGY
G.C. DUKE EQUIPMENT LTD.
GROOMERS, GOLF
CLEAN TURF CANADA INC.
G.C. DUKE EQUIPMENT LTD.
TURF CARE PRODUCTS CANADA
GROOMERS, SPORT TURF
CLEAN TURF CANADA INC.
FIBRAMULCH
G.C. DUKE EQUIPMENT LTD.
TURF CARE PRODUCTS CANADA
GROWTH ENHANCERS
BELCHIM TURF PROTECTION CANADA
FIBRAMULCH
MARMIC SOLUTIONS
PLANT PRODUCTS
HYDROSEEDING
FIBRAMULCH
INSECT/MOSQUITO CONTROL
FISH FARM SUPPLY CO. INC.
PILGRIM PEST PROFESSIONALS
PLANT PRODUCTS
IRRIGATION
HYBRIDTURF.COM
RAIN BIRD CORPORATION
THE TORO COMPANY RES/COM
IRRIGATION
TURF CARE PRODUCTS CANADA
TURF TALENTS INC.
VANDEN BUSSCHE IRRIGATION
LAKE/POND MANAGEMENT
FISH FARM SUPPLY CO. INC.
MINROCK TECHNOLOGIES INC.
PLANT PRODUCTS
TURF CARE PRODUCTS CANADA
VANDEN BUSSCHE IRRIGATION
LANDSCAPING EQUIPMENT, HANDHELD (BATTERY)
ECHO POWER EQUIPMENT (CANADA)
G.C. DUKE EQUIPMENT LTD.
GREENWORKS TOOLS CANADA
STIHL LIMITED
TROJAN BATTERY COMPANY
TURF CARE PRODUCTS CANADA
LANDSCAPING EQUIPMENT, HANDHELD (GAS)
ECHO POWER EQUIPMENT (CANADA)
FIBRAMULCH
G.C. DUKE EQUIPMENT LTD.
GENERAL EQUIPMENT COMPANY
STIHL LIMITED
TURF CARE PRODUCTS CANADA
LANDSCAPING SUPPLIES/MATERIALS
ACTION SUPPLIES INC.
EARTHCO SOIL MIXTURES
FIBRAMULCH
LESS MESS ENVIRO BAG
PLANT PRODUCTS
STIHL LIMITED
TROJAN BATTERY COMPANY
TURF CARE PRODUCTS CANADA
VANDEN BUSSCHE IRRIGATION
LIGHTING
MAKITA CANADA INC.
THE TORO COMPANY RES/COM
IRRIGATION
TURF CARE PRODUCTS CANADA
VANDEN BUSSCHE IRRIGATION
MOWERS (BATTERY-POWERED)
G.C. DUKE EQUIPMENT LTD.
GREENWORKS TOOLS CANADA
TURF CARE PRODUCTS CANADA
MOWERS (GAS-POWERED)
G.C. DUKE EQUIPMENT LTD.
TURF CARE PRODUCTS CANADA
MOWERS, GOLF
BANNERMAN LTD.
BROUWER KESMAC
CUB CADET
G.C. DUKE EQUIPMENT LTD.
GREENWORKS TOOLS CANADA
MAKITA CANADA INC.
TURF CARE PRODUCTS CANADA
MOWERS, LANDSCAPING
CUB CADET
ECHO POWER EQUIPMENT (CANADA)
G.C. DUKE EQUIPMENT LTD.
GREENWORKS TOOLS CANADA
STIHL LIMITED
TURF CARE PRODUCTS CANADA
MULCH
DIRT CHEAP INC. - KITCHENER
DRAGLAM SALT
EARTHCO SOIL MIXTURES
FIBRAMULCH
LESS MESS ENVIRO BAG
QUALITY SEEDS LTD.
NETTING/FENCING
FIBRAMULCH
REDDEN NET CUSTOM NETS LTD.
SKY LINE NET INSTALLATIONS INC.
PEAT
EARTHCO SOIL MIXTURES
PLANT PRODUCTS
PIPING, GOLF COURSE
TURF CARE PRODUCTS CANADA
VANDEN BUSSCHE IRRIGATION
PLANT MATERIALS
EARTHCO SOIL MIXTURES
PUMPS/PUMPING STATIONS
ECHO POWER EQUIPMENT (CANADA)
RAIN BIRD CORPORATION
TURF CARE PRODUCTS CANADA
VANDEN BUSSCHE IRRIGATION
REEL GRINDING EQUIPMENT
G.C. DUKE EQUIPMENT LTD.
TURF CARE PRODUCTS CANADA
SAND AND MIXES (GOLF)
BROCK AGGREGATES INC.
EARTHCO SOIL MIXTURES
G.C. DUKE EQUIPMENT LTD.
LAKE SHORE SAND
LESS MESS ENVIRO BAG
SAND AND MIXES (OTHER)
BROCK AGGREGATES INC.
EARTHCO SOIL MIXTURES
LESS MESS ENVIRO BAG
SEED
DLF PICKSEED CANADA INC.
FIBRAMULCH
GENERAL SEED COMPANY
PLANT PRODUCTS
QUALITY SEEDS LTD.
TARGET SPECIALTY PRODUCTS
TURF CARE PRODUCTS CANADA
SEEDERS
BANNERMAN LTD.
CLEAN TURF CANADA INC.
EASTERN FARM MACHINERY LTD.
ECHO POWER EQUIPMENT (CANADA)
FIBRAMULCH
G.C. DUKE EQUIPMENT LTD.
TURF CARE PRODUCTS CANADA

SIGNAGE
BAG-A-SIGN
PROFESSIONAL LAWN CARE
ASSOCIATION OF ONTARIO
SNOW REMOVAL EQUIPMENT/ BLOWERS
FIBRAMULCH
G.C. DUKE EQUIPMENT LTD.
GREENWORKS TOOLS CANADA
TURF CARE PRODUCTS CANADA
SNOW/ICE REMOVAL, SALT/DE-ICERS
BAUMAN MANUFACTURING
CANADASALT GROUP LTD
CUB CADET
DRAGLAM SALT
G.C. DUKE EQUIPMENT LTD.
HLA SNOW
MECALAC NORTH AMERICA
PLANT PRODUCTS
TURF CARE PRODUCTS CANADA
SOIL ANALYSIS
EARTHCO SOIL MIXTURES
HYBRIDTURF.COM
LESS MESS ENVIRO BAG
PLANT PRODUCTS
TURF TALENTS INC.
SOIL CONDITIONERS/AMENDMENTS/ MIXTURES
BELCHIM TURF PROTECTION CANADA
DRAGLAM SALT
EARTHCO SOIL MIXTURES
FIBRAMULCH
MARMIC SOLUTIONS
MINROCK TECHNOLOGIES INC.
PLANT PRODUCTS
SOIL PREPARATION FIBRAMULCH
SPORT CLAY PRODUCTS
PLANT PRODUCTS
SPRAYERS
ECHO POWER EQUIPMENT (CANADA)
FIBRAMULCH
G.C. DUKE EQUIPMENT LTD.
TURF CARE PRODUCTS CANADA
SPREADERS
ANDERSONS, THE
BAUMAN MANUFACTURING
CUB CADET
EASTERN FARM MACHINERY LTD.
ECHO POWER EQUIPMENT (CANADA)
G.C. DUKE EQUIPMENT LTD.
TURF CARE PRODUCTS CANADA
SYNTHETIC TURF SUPPLIES/ EQUIPMENT
CLEAN TURF CANADA INC.
G.C. DUKE EQUIPMENT LTD.
GEORGE DE GROOT LASER GRADING & EXCAVATING INC.
HYBRIDTURF.COM
TURF CARE PRODUCTS CANADA
TURF TALENTS INC.
VANDEN BUSSCHE IRRIGATION



TOPDRESSING MATERIALS/ EQUIPMENT
BANNERMAN LTD.
EARTHCO SOIL MIXTURES
EASTERN FARM MACHINERY LTD.
FIBRAMULCH
G.C. DUKE EQUIPMENT LTD.
LESS MESS ENVIRO BAG
PLANT PRODUCTS
TURF CARE PRODUCTS CANADA
TRAILERS
SOUTHEND EQUIPT TRAILERS
TALBERT MANUFACTURING
TREE CARE EQUIPMENT
EASTERN FARM MACHINERY LTD.
ECHO POWER EQUIPMENT (CANADA)
G.C. DUKE EQUIPMENT LTD.
MAKITA CANADA INC.
PLANT PRODUCTS
STIHL LIMITED
TREE CARE SUPPLIES
PLANT PRODUCTS
ACTION SUPPLIES INC.
51 Observatory Ln
Richmond Hill ON L4C 8K9
Tel: 647-227-1357
e-mail: info@actionsupplies.ca
Website: actionsupplies.ca
AGRIMETAL
1006 Principale
Wickham QC J0C 1S0
Tel: 819-398-6883
Fax: 819-398-5311
e-mail: service@agrimetal.com
Website: agrimetal.com
BELCHIM TURF PROTECTION
CANADA
104 Cooper Dr., Unit 3
Guelph ON N1C 0A4
Tel: 519-826-7878
Toll free: 866-613-3336
Fax: 519-826-7675
e-mail: barry.johnson@belchim.com
Website: belchimturf.ca
BUFFALO TURBINE
180 Zoar Valley Road
Springville NY 14141
Tel: 716-592-2700
e-mail: btsales@buffaloturbine.com
Website: buffaloturbine.com
BUILTRIGHT
131 Continental Drive
Newark DE 19713
Tel: 470-264-9485
e-mail: team@builtright.com
Website: builtright.co
CANADASALT GROUP LTD
10638 9th Line, Markham, ON Markham BC L6B 1A8
Tel: 866-321-7258
e-mail: sales@canadasalt.ca
Website: canadasalt.ca
TURF CARE ACCESSORIES
BELCHIM TURF PROTECTION CANADA
EVERGREEN TURF COVERS
FIBRAMULCH
G.C. DUKE EQUIPMENT LTD.
PLANT PRODUCTS
TROJAN BATTERY COMPANY
TURF CARE PRODUCTS CANADA
VANDEN BUSSCHE IRRIGATION
TURF COVERS
EVERGREEN TURF COVERS
TURF POWER EQUIPMENT
BANNERMAN LTD.
BROUWER KESMAC
BUFFALO TURBINE
CUB CADET
ECHO POWER EQUIPMENT (CANADA)
FIBRAMULCH
G.C. DUKE EQUIPMENT LTD.
MAKITA CANADA INC.
MECALAC NORTH AMERICA
TROJAN BATTERY COMPANY
TURF CARE PRODUCTS CANADA
DR MOWER PARTS
5-1304-44 Ave NE
Calgary AB T2E 6L6
Tel: 587-329-6642
Toll free: 877-531-2873
e-mail: parts@drmower.ca
Website: drmower.ca

FIBRAMULCH
29 Killaloe Rd, Unit 2
CONCORD ON L4K 2A8
Tel: 905-761-6969
Website: fibramulch.com
Description: For almost 50 years, FIBRAMULCH has delivered knowledgeable advice, service, rentals and products for Erosion Control, Sediment Control & Land Reclamation. Proud partners of DLF, LSC, Profile, FINN, ABI & TurfTeq. We’re your one-stopshop—call us today!
GREENWORKS TOOLS CANADA
67 Toll Rd
Holland Landing ON L9N 1H2
Tel: 416-859-9878
e-mail: gwcanadaprograms@ greenworkstools.com
MAKITA CANADA INC.
1950 Forbes Street
Whitby ON L1N 7B7
Tel: 905-809-0152
Toll free: 800-263-3734
e-mail: s.ottewell@makita.ca Website: makita.ca
TURF TIRES
CUB CADET
TURF CARE PRODUCTS CANADA
VACUUMS
BROUWER KESMAC
CLEAN TURF CANADA INC.
G.C. DUKE EQUIPMENT LTD.
MAKITA CANADA INC.
TURF CARE PRODUCTS CANADA
WATER GARDENS
FISH FARM SUPPLY CO. INC.
WEATHER MONITORING
TURF CARE PRODUCTS CANADA
WETTING AGENTS
FIBRAMULCH
MARMIC SOLUTIONS
PLANT PRODUCTS
TARGET SPECIALTY PRODUCTS
MARMIC SOLUTIONS
795 Rathbourne Ave
Woodstock ON N4S 4L8
Tel: 519-421-6783
e-mail: mkean@mjkean.com
Website: marmicsolutions.com
MECALAC NORTH AMERICA
282 Dedham Street
Norfolk MA 02056
Tel: 508-921-3076
e-mail: mecalac.northamerica@mecalac. com
Website: mecalac.com/en
MINROCK TECHNOLOGIES INC.
PO. Box 1522, Woodstock Station Main Woodstock ON N4S 0A7
Tel: 519-421-6783
e-mail: mkean@mjkean.com Website: minrocktechnologies.com
NUTRITE, A DIVISION OF FERTI-TECHNOLOGIES INC.
560 Chemin Rheaume
St. Michel QC J0L 2J0
Tel: 450-454-5367
Toll free: 800-265-8865
e-mail: kmcleod@fertitechno.com Website: nutrite.com
OJ COMPAGNIE
294 Rang St-Paul Sherrington QC J0L 2N0
Tel: 450-247-2758
Toll free: 800-596-6886
Fax: 450-247-3195
e-mail: info@ojcompagnie.com
Website: ojcompagnie.com
PILGRIM PEST PROFESSIONALS
26 Palmer Rd Plymouth MA 02360
Tel: 508-208-3864
e-mail: marketing@pilgrimpestpro.com Website: pilgrimpestpro.com/pest-control
PLANT PRODUCTS
3370 Le Corbusier
Laval QC H7L 4S8
Tel: 450-682-6110
Toll free: 800-361-9187
Fax: 450-682-6117
e-mail: info@plantproducts.com
Website: plantproducts.com
Description: Full line distributor of pest control, fertilizer and other consumable goods. Trusted partner in the industry for over 75 years.
RAIN BIRD CORPORATION
6991 East Southpoint Road
Tucson AZ 85756
Tel: 587-575-5775
e-mail: dzabel@rainbird.com
Website: rainbird.com
REDDEN NET CUSTOM NETS LTD.
5620 198th St.
Langley BC V3A 7C7
Tel: 604-530-2213
Toll free: 800-667-9455
Fax: 604-530-2218
e-mail: info@redden-net.com
Website: redden-net.com
SKY LINE NET INSTALLATIONS INC.
21458 24th Ave.
Langley BC V2Z 2A8
Tel: 604-328-1474
e-mail: greg@skynets.ca
Website: skynets.ca
TALBERT MANUFACTURING
1628 W. State Road 114
Rensselaer IN 47978
Tel: 800-348-5232
e-mail: sales@talbertmfg.com
Website: talbertmfg.com
TROJAN BATTERY COMPANY
12380 Clark Street
Santa Fe Springs CA 90670
Tel: 800-423-6569
e-mail: technical@trojanbattery.com
Website: trojanbattery.com

TURF CARE PRODUCTS CANADA
2499 Rang Saint-Antoine
Vaudreuil-Dorion QC J7V 8P2
Tel: 450-218-4544
Toll free: 855-290-0518
e-mail: inquiries@turfcare.ca
Website: turfcare.ca
Description: Turf Care is the exclusive Toro Distributor for Eastern Canada as well as representing a wide range of other industry-leading brands including Ventrac, Kawasaki, and Yamaha. Proudly supplying superior quality turf equipment, irrigation systems, pumps, golf cars, parts, and accessories to golf courses, municipalities, corporations, contractors and dealers across Eastern Canada for nearly 50 years.
TURF CARE PRODUCTS CANADA
114 Ave. Labrosse
Pointe Claire QC H9R 1A1
Tel: 514-694-6630
Toll free: 800-361-5594
e-mail: inquiries@turfcare.ca
Website: turfcare.ca
Description: Turf Care is the exclusive Toro Distributor for Eastern Canada as well as representing a wide range of other industry-leading brands including Ventrac, Kawasaki, and Yamaha. Proudly supplying superior quality turf equipment, irrigation systems, pumps, golf cars, parts, and accessories to golf courses, municipalities, corporations, contractors and dealers across Eastern Canada for nearly 50 years.

AERATION/OVERSEEDING SERVICE FIBRAMULCH
AERATORS - SOIL
AGRIMETAL FIBRAMULCH
OJ COMPAGNIE
TURF CARE PRODUCTS CANADA
AERATORS - WATER
TURF CARE PRODUCTS CANADA
ARCHITECTS, SPORTS FIELDS
REDDEN NET CUSTOM NETS LTD.
SKY LINE NET INSTALLATIONS INC.
ARCHITECTS/CONTRACTORS, GOLF COURSE
REDDEN NET CUSTOM NETS LTD. SKY LINE NET INSTALLATIONS INC.
AUTONOMOUS EQUIPMENT
TURF CARE PRODUCTS CANADA
BALL DIAMOND GREEN FIBRAMULCH
BLOWER TRUCK OR MATERIAL
BLOWER FIBRAMULCH
BUNKER MAINTENANCE
OJ COMPAGNIE
PLANT PRODUCTS
TURF CARE PRODUCTS CANADA
BUSINESS SOFTWARE BUILTRIGHT
CHEMICALS
BELCHIM TURF PROTECTION CANADA
OJ COMPAGNIE
PLANT PRODUCTS
CONSULTING SKY LINE NET INSTALLATIONS INC.
DRAINAGE
TURF CARE PRODUCTS CANADA
EARTHMOVING EQUIPMENT
MECALAC NORTH AMERICA
TURF CARE PRODUCTS CANADA
ENGINES
TURF CARE PRODUCTS CANADA
EQUIPMENT PARTS
DR MOWER PARTS
FIBRAMULCH
TURF CARE PRODUCTS CANADA
EQUIPMENT RENTALS
FIBRAMULCH
TURF CARE PRODUCTS CANADA
EROSION CONTROL
FIBRAMULCH
FENCING
FIBRAMULCH
REDDEN NET CUSTOM NETS LTD.
SKY LINE NET INSTALLATIONS INC.
FERTILIZER
FIBRAMULCH
MARMIC SOLUTIONS
MINROCK TECHNOLOGIES INC.
OJ COMPAGNIE
PLANT PRODUCTS
GOLF COURSE ACCESSORIES
OJ COMPAGNIE
PLANT PRODUCTS
REDDEN NET CUSTOM NETS LTD.
TURF CARE PRODUCTS CANADA
GROOMERS, GOLF
OJ COMPAGNIE
TURF CARE PRODUCTS CANADA
GROOMERS, SPORT TURF
FIBRAMULCH
OJ COMPAGNIE
TURF CARE PRODUCTS CANADA
GROWTH ENHANCERS
BELCHIM TURF PROTECTION CANADA
FIBRAMULCH
MARMIC SOLUTIONS
OJ COMPAGNIE
PLANT PRODUCTS
HYDROSEEDING
FIBRAMULCH
INSECT/MOSQUITO CONTROL
PILGRIM PEST PROFESSIONALS
PLANT PRODUCTS
IRRIGATION
RAIN BIRD CORPORATION
TURF CARE PRODUCTS CANADA
LAKE/POND MANAGEMENT
MINROCK TECHNOLOGIES INC.
OJ COMPAGNIE
PLANT PRODUCTS
TURF CARE PRODUCTS CANADA
LANDSCAPING EQUIPMENT, HANDHELD (BATTERY)
GREENWORKS TOOLS CANADA
OJ COMPAGNIE
TROJAN BATTERY COMPANY
TURF CARE PRODUCTS CANADA
LANDSCAPING EQUIPMENT, HANDHELD (GAS)
FIBRAMULCH
TURF CARE PRODUCTS CANADA
LANDSCAPING SUPPLIES/MATERIALS
ACTION SUPPLIES INC.
FIBRAMULCH
OJ COMPAGNIE
PLANT PRODUCTS
TROJAN BATTERY COMPANY
LIGHTING
MAKITA CANADA INC.
TURF CARE PRODUCTS CANADA
MOWERS (BATTERY-POWERED)
GREENWORKS TOOLS CANADA
TURF CARE PRODUCTS CANADA
MOWERS (GAS-POWERED)
TURF CARE PRODUCTS CANADA
MOWERS, GOLF
GREENWORKS TOOLS CANADA
MAKITA CANADA INC.
OJ COMPAGNIE
TURF CARE PRODUCTS CANADA
MOWERS, LANDSCAPING
GREENWORKS TOOLS CANADA
OJ COMPAGNIE
TURF CARE PRODUCTS CANADA
MULCH
FIBRAMULCH
OJ COMPAGNIE
NETTING/FENCING
FIBRAMULCH
REDDEN NET CUSTOM NETS LTD.
SKY LINE NET INSTALLATIONS INC.
PEAT PLANT PRODUCTS
PIPING, GOLF COURSE
TURF CARE PRODUCTS CANADA
PUMPS/PUMPING STATIONS
RAIN BIRD CORPORATION
TURF CARE PRODUCTS CANADA
REEL GRINDING EQUIPMENT
OJ COMPAGNIE
TURF CARE PRODUCTS CANADA
SAND AND MIXES (GOLF)
OJ COMPAGNIE
SEED
FIBRAMULCH
OJ COMPAGNIE
PLANT PRODUCTS
SEEDERS
AGRIMETAL
FIBRAMULCH
OJ COMPAGNIE
TURF CARE PRODUCTS CANADA
SNOW REMOVAL EQUIPMENT/ BLOWERS
FIBRAMULCH
GREENWORKS TOOLS CANADA
TURF CARE PRODUCTS CANADA
SNOW/ICE REMOVAL, SALT/DE-ICERS
CANADASALT GROUP LTD
MECALAC NORTH AMERICA
OJ COMPAGNIE
PLANT PRODUCTS
TURF CARE PRODUCTS CANADA
SOIL ANALYSIS
OJ COMPAGNIE
PLANT PRODUCTS
SOIL CONDITIONERS/AMENDMENTS/ MIXTURES
BELCHIM TURF PROTECTION CANADA
FIBRAMULCH
MARMIC SOLUTIONS
MINROCK TECHNOLOGIES INC.
OJ COMPAGNIE
PLANT PRODUCTS
SOIL PREPARATION
FIBRAMULCH
SPORT CLAY PRODUCTS
PLANT PRODUCTS
SPRAYERS
FIBRAMULCH
TURF CARE PRODUCTS CANADA
SPREADERS
OJ COMPAGNIE
TURF CARE PRODUCTS CANADA
SYNTHETIC TURF SUPPLIES/ EQUIPMENT
TURF CARE PRODUCTS CANADA



TOPDRESSING MATERIALS/ EQUIPMENT
FIBRAMULCH
OJ COMPAGNIE
PLANT PRODUCTS
TURF CARE PRODUCTS CANADA
TRAILERS
TALBERT MANUFACTURING
TREE CARE EQUIPMENT
MAKITA CANADA INC.
PLANT PRODUCTS
TREE CARE SUPPLIES
PLANT PRODUCTS
TURF CARE ACCESSORIES
BELCHIM TURF PROTECTION CANADA
FIBRAMULCH
PLANT PRODUCTS
TROJAN BATTERY COMPANY
TURF CARE PRODUCTS CANADA
TURF POWER EQUIPMENT
AGRIMETAL
BUFFALO TURBINE
FIBRAMULCH
MAKITA CANADA INC.
MECALAC NORTH AMERICA
TROJAN BATTERY COMPANY
TURF CARE PRODUCTS CANADA



TURF TIRES
OJ COMPAGNIE
TURF CARE PRODUCTS CANADA
VACUUMS
AGRIMETAL
MAKITA CANADA INC.
OJ COMPAGNIE
TURF CARE PRODUCTS CANADA
WEATHER MONITORING
TURF CARE PRODUCTS CANADA
WETTING AGENTS
FIBRAMULCH
MARMIC SOLUTIONS
OJ COMPAGNIE
PLANT PRODUCTS
ACTION SUPPLIES INC.
51 Observatory Ln
Richmond Hill ON L4C 8K9
Tel: 647-227-1357
e-mail: info@actionsupplies.ca
Website: actionsupplies.ca
BELCHIM TURF PROTECTION
CANADA
104 Cooper Dr., Unit 3
Guelph ON N1C 0A4
Tel: 519-826-7878
Toll free: 866-613-3336
Fax: 519-826-7675
e-mail: barry.johnson@belchim.com Website: belchimturf.ca
BUFFALO TURBINE
180 Zoar Valley Road
Springville NY 14141
Tel: 716-592-2700
e-mail: btsales@buffaloturbine.com
Website: buffaloturbine.com
BUILTRIGHT
131 Continental Drive
Newark DE 19713
Tel: 470-264-9485
e-mail: team@builtright.com
Website: builtright.co
CANADASALT GROUP LTD
10638 9th Line, Markham, ON Markham BC L6B 1A8
Tel: 866-321-7258
e-mail: sales@canadasalt.ca
Website: canadasalt.ca
COLONIAL AUTO PARTS
355 Hamilton Ave.
St. John’s NL A1C 5K4
Tel: 709-579-4011
Fax: 709-579-9600
e-mail: info@colonialautoparts.ca
Website: colonialautoparts.ca
CUB CADET
Tel: 800-668-1238
Toll free: 800-668-1238
Fax: 800-668-6677
e-mail: kevindunbar@cubcadet.com Website: cubcadet.ca
DR MOWER PARTS
5-1304-44 Ave NE
Calgary AB T2E 6L6
Tel: 587-329-6642
Toll free: 877-531-2873
e-mail: parts@drmower.ca
Website: drmower.ca

FIBRAMULCH
29 Killaloe Rd, Unit 2
CONCORD ON L4K 2A8
Tel: 905-761-6969
Website: fibramulch.com
Description: For almost 50 years, FIBRAMULCH has delivered knowledgeable advice, service, rentals and products for Erosion Control, Sediment Control & Land Reclamation. Proud partners of DLF, LSC, Profile, FINN, ABI & TurfTeq. We’re your one-stopshop—call us today!
GREENWORKS TOOLS CANADA
67 Toll Rd
Holland Landing ON L9N 1H2
Tel: 416-859-9878
e-mail: gwcanadaprograms@ greenworkstools.com
MAKITA CANADA INC.
1950 Forbes Street
Whitby ON L1N 7B7
Tel: 905-809-0152
Toll free: 800-263-3734
e-mail: s.ottewell@makita.ca
Website: makita.ca
MARMIC SOLUTIONS
795 Rathbourne Ave
Woodstock ON N4S 4L8
Tel: 519-421-6783
e-mail: mkean@mjkean.com
Website: marmicsolutions.com
MECALAC NORTH AMERICA
282 Dedham Street
Norfolk MA 02056
Tel: 508-921-3076
e-mail: mecalac.northamerica@mecalac. com
Website: mecalac.com/en
MINROCK TECHNOLOGIES INC.
PO. Box 1522, Woodstock Station Main Woodstock ON N4S 0A7
Tel: 519-421-6783
e-mail: mkean@mjkean.com Website: minrocktechnologies.com
PILGRIM PEST PROFESSIONALS
26 Palmer Rd
Plymouth MA 02360
Tel: 508-208-3864
e-mail: marketing@pilgrimpestpro.com Website: pilgrimpestpro.com/pest-control
RAIN BIRD CORPORATION
6991 East Southpoint Road
Tucson AZ 85756
Tel: 587-575-5775
e-mail: dzabel@rainbird.com
Website: rainbird.com
REDDEN NET CUSTOM NETS LTD.
5620 198th St.
Langley BC V3A 7C7
Tel: 604-530-2213
Toll free: 800-667-9455
Fax: 604-530-2218
e-mail: info@redden-net.com
Website: redden-net.com
SKY LINE NET INSTALLATIONS INC.
21458 24th Ave. Langley BC V2Z 2A8
Tel: 604-328-1474
e-mail: greg@skynets.ca Website: skynets.ca
TALBERT MANUFACTURING
1628 W. State Road 114
Rensselaer IN 47978
Tel: 800-348-5232
e-mail: sales@talbertmfg.com Website: talbertmfg.com
TROJAN BATTERY COMPANY
12380 Clark Street
Santa Fe Springs CA 90670
Tel: 800-423-6569
e-mail: technical@trojanbattery.com Website: trojanbattery.com
AERATION/OVERSEEDING SERVICE FIBRAMULCH
AERATORS - SOIL FIBRAMULCH
ARCHITECTS, SPORTS FIELDS
REDDEN NET CUSTOM NETS LTD. SKY LINE NET INSTALLATIONS INC.
ARCHITECTS/CONTRACTORS, GOLF COURSE
REDDEN NET CUSTOM NETS LTD. SKY LINE NET INSTALLATIONS INC.
BALL DIAMOND GREEN FIBRAMULCH
BLOWER TRUCK OR MATERIAL BLOWER FIBRAMULCH
BUSINESS SOFTWARE BUILTRIGHT
CHEMICALS
BELCHIM TURF PROTECTION CANADA
CONSULTING
SKY LINE NET INSTALLATIONS INC.
EARTHMOVING EQUIPMENT
MECALAC NORTH AMERICA
EQUIPMENT PARTS
DR MOWER PARTS FIBRAMULCH
EQUIPMENT RENTALS FIBRAMULCH
EROSION CONTROL FIBRAMULCH
FENCING
FIBRAMULCH
REDDEN NET CUSTOM NETS LTD.
SKY LINE NET INSTALLATIONS INC.
FERTILIZER
FIBRAMULCH
MARMIC SOLUTIONS MINROCK TECHNOLOGIES INC.
GOLF COURSE ACCESSORIES
REDDEN NET CUSTOM NETS LTD.
GROOMERS, SPORT TURF FIBRAMULCH
GROWTH ENHANCERS
BELCHIM TURF PROTECTION CANADA
FIBRAMULCH
MARMIC SOLUTIONS
HYDROSEEDING FIBRAMULCH
INSECT/MOSQUITO CONTROL
PILGRIM PEST PROFESSIONALS
IRRIGATION
RAIN BIRD CORPORATION
LAKE/POND MANAGEMENT MINROCK TECHNOLOGIES INC.
LANDSCAPING EQUIPMENT, HANDHELD (BATTERY)
GREENWORKS TOOLS CANADA
TROJAN BATTERY COMPANY
LANDSCAPING EQUIPMENT, HANDHELD (GAS) FIBRAMULCH
LANDSCAPING SUPPLIES/MATERIALS ACTION SUPPLIES INC. FIBRAMULCH
TROJAN BATTERY COMPANY
LIGHTING
MAKITA CANADA INC.
MOWERS (BATTERY-POWERED)
GREENWORKS TOOLS CANADA
MOWERS, GOLF
CUB CADET
GREENWORKS TOOLS CANADA
MAKITA CANADA INC.
MOWERS, LANDSCAPING
CUB CADET
GREENWORKS TOOLS CANADA
MULCH
FIBRAMULCH
NETTING/FENCING
FIBRAMULCH
REDDEN NET CUSTOM NETS LTD.
SKY LINE NET INSTALLATIONS INC.
PUMPS/PUMPING STATIONS
RAIN BIRD CORPORATION
SEED FIBRAMULCH
SEEDERS FIBRAMULCH
SNOW REMOVAL EQUIPMENT/ BLOWERS
FIBRAMULCH
GREENWORKS TOOLS CANADA
SNOW/ICE REMOVAL, SALT/DE-ICERS
CANADASALT GROUP LTD
CUB CADET
MECALAC NORTH AMERICA
SOIL CONDITIONERS/AMENDMENTS/ MIXTURES
BELCHIM TURF PROTECTION CANADA
FIBRAMULCH
MARMIC SOLUTIONS
MINROCK TECHNOLOGIES INC.
SOIL PREPARATION
FIBRAMULCH
SPRAYERS
FIBRAMULCH
SPREADERS CUB CADET
TOPDRESSING MATERIALS/ EQUIPMENT
FIBRAMULCH
TRAILERS
TALBERT MANUFACTURING
TREE CARE EQUIPMENT
MAKITA CANADA INC.
TURF CARE ACCESSORIES
BELCHIM TURF PROTECTION CANADA
FIBRAMULCH
TROJAN BATTERY COMPANY
TURF POWER EQUIPMENT
BUFFALO TURBINE
COLONIAL AUTO PARTS
CUB CADET
FIBRAMULCH
MAKITA CANADA INC.
MECALAC NORTH AMERICA
TROJAN BATTERY COMPANY
TURF TIRES
CUB CADET
VACUUMS
MAKITA CANADA INC.
WETTING AGENTS
FIBRAMULCH
MARMIC SOLUTIONS


By CCOHS
The Canadian Centre for Occupational Health and Safety (CCOHS) promotes the total well being of workers in Canada by providing information, training, education, systems and solutions that support health and safety programs and injury and illness prevention. www.ccohs.ca
Anaphylaxis is a serious health concern that can strike suddenly and without warning. Awareness, prevention, and preparedness are critical. With proper planning, education and response protocols in place, the devastating consequences of a severe allergic reaction can be managed.
Anaphylaxis can affect multiple organs and systems throughout the body. Allergic reactions can range from mild, affecting only the skin, to severe, affecting the airways or the heart, possibly resulting in death. Symptoms can occur in various combinations and may be hard to recognize, such as:
• itching and/or swelling of the lips, tongue, palate, and throat
• swelling of the eyelids, and itchy, watery eyes
• hives, itching, flushing, or swelling of the skin
• rapid heart rate
• abdominal cramps, nausea, vomiting, diarrhea
• difficulty breathing, wheezing, and asthma
• a feeling of impending doom
• weakness, faintness, and loss of consciousness
Severe symptoms can develop within minutes after being exposed to an allergen, and the severity usually peaks within three to 30 minutes. There can also be an equally serious second phase reaction, one to eight hours after the initial anaphylactic episode.
Causes
Anaphylaxis can be triggered by many different allergens, the most common being those found in certain foods such as peanuts and shellfish, and in insect venom from bee or wasp stings. These severe allergic reactions may also be caused by medications,
certain chemicals (for example, diisocyanates), latex, and less commonly, exercising within two to four hours after eating an allergenic food.
Workers have the right to be informed about the hazards they may be exposed to and how to work safely. They may also wish to inform their employer about any allergies they may have, including those that are not directly controlled by the workplace. In addition, human rights legislation specifies that employers have a “duty to accommodate” a worker’s needs in relation to a disease or disability (either mental or physical). Each situation is unique, and any accommodation would need to be evaluated on a case-by-case basis. An accommodation is a modification to rules, policies, practices, or tasks to ensure that a person can fully participate in the workplace without discrimination.
While it may not be possible to completely eliminate the risk of anaphylaxis in the workplace, both employers and workers can take steps to reduce the risk.
The main efforts to prevent work-related anaphylaxis centre on avoiding worker exposure to sensitizers whether at the source (elimination, substitution, local exhaust ventilation), along the path (enclosure of emission source) or at the worker level (administrative controls, respiratory protective equipment). Employers are encouraged to consult experts such as engineers and occupational hygienists to find ways to substitute or eliminate allergens from the workplace.
Epinephrine is a common first-line treatment for anaphylaxis. If a person requires epinephrine, make sure the employer is informed and that first aid attendants are trained in its use. However, other first aid measures may be needed because many people don’t know they have an allergy until their first anaphylactic reaction occurs.
• Ask workers if they have a life-threatening allergy to certain foods, insect bites, medications, chemicals, or other materials.
• Educate workers about the dangers of anaphylaxis, how to recognize and respond to its signs, and how best to avoid known allergens.
• Promote handwashing, cleaning and disinfecting work surfaces, and properly handling and/or preparing food.
• Obtain permission from workers with allergies to make information and identification sheets about them (photographs, allergens to avoid, and an emergency response plan) readily available to first aid attendants or others as necessary in the workplace.
• Teach workers how to recognize the signs and symptoms of an allergic reaction and how to use an epinephrine auto-injector properly.
• Provide immediate assistance if a worker is unable to self-administer the epinephrine auto-injector due to the severity of the anaphylactic symptoms; a delay could be fatal.
• Ensure that the worker gets immediate emergency medical treatment after use of the epinephrine auto-injector either by calling 911 for medical assistance and/or taking the person immediately to an emergency care facility.
• Tell your manager and co-workers about your allergies and help create your emergency response plan together.
• Always keep an epinephrine auto-injector with you, and another labelled with your name, in a readily available location at work. Note that these auto-injectors expire - replace them as necessary.
• Wear identification such as a medical alert bracelet or necklace.
Easily create maps, set mowing schedules, manage charging stations, customize working zones, and more. All from the Kress app in your pocket. Your fleet is at your fingertips


The robotic mower trusted by the world's finest golf courses Scan this code to find out how Kress is redefining turf maintenance worldwide




With the new WiseNav update, say goodbye to boundary wire limitations. This update will take your robot's precision to the next level. Now, navigate without the need for a boundary wire, providing three times more mowing capacity and significantly reducing your workload. This update is also applicable to golf ball pickers.
Exclusively available for GPS-RTK robot models.

PATTERN MOWING & PICKING
With centimeter accuracy
FULLY AUTONOMOUS
Charges, Cuts & Dispenses golf balls on its own
COMBINES WITH TM-2050
MULTI-ZONE OPERATION
Use on sport fields, parks and golf courses
SUSTAINABILITY AND RELIABILITY
Zero emissions with zero noise pollution
For a complete autonomous solution for your driving range








The ECHO X Series is a collection of best-in-class tools, engineered for professionals to conquer the toughest jobs e ortlessly. This powerful lineup of battery-powered equipment maximizes productivity and e ciency, ensuring peak performance on every task. Backed by a two-year commercial warranty, you can trust in their superior quality and reliability.

